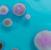

ERSTE HILFE GEGEN GERUCH
ÜBERNEHMEN SIE 100% KONTROLLE

ÜBER IHRE GERUCHSBESEITIGUNG

ERSTE HILFE GEGEN GERUCH
ÜBERNEHMEN SIE 100% KONTROLLE

ÜBER IHRE GERUCHSBESEITIGUNG
Vaportek Geruchsentfernung mit den Kräften der Natur. Kompletter Produktkatalog und Gebrauchsanweisung.




Since 1979
ERFOLG IN DER GLOBALEN BRAND- UND WASSERSCHADENSANIERUNG
Seit 1979 ist Vaportek führend mit bahnbrechenden Produkten für die Geruchssanierung, die auf Basis natürlicher ätherischer Öle sind.


SCHADENSANIERER IN EUROPA KATALOG 2025
EXKLUSIVDISTRIBUTOR FÜR DIE







Seit der Gründung des Unternehmens im Jahr 1979 haben sich Vaporteks weltweit einzigartige Technologie und Produkte auf der Basis ätherischer Öle bewährt. Die Produkte genießen heute große Anerkennung unter den globalen Schadensanierern für ihre Effizienz und ihre äußerst vielseitige Verwendung bei
der Geruchssanierung. Professionelle Fachleute in der Schadensanierung betrachten die Produkte heute als unverzichtbares Werkzeug zur Beseitigung von Geruchsproblemen nach Brand- und Wasserschäden usw.
Kein anderes Geruchssanierungs-Konzept ist so vielseitig und effektiv anzuwenden wie Vaportek
BEI PLÖTZLICH AUFTRETENDEN GERUCHSBELÄSTIGUNGENEN Z.B. NACH EINEM BRAND, GEHT ES DARUM PROAKTIV ZU SEIN UND SCHNELL ZU REAGIEREN. DAS GIBT ZUFRIEDENE KUNDEN!

PROAKTIV
HELFEN SIE
IHREN KUNDEN
SOFORT
Die vielseitigen und wirksamen Produkte von Vaportek reduzieren sofort, ohne Risiko für Umwelt und Menschen, den negativen Rauch/Rußgeruch, der nach einem Brand im Gebäude herrscht. Warten Sie nicht bis sich der Kunde über den plötzlichen Geruch beschwert. Ergreifen Sie selbst die Initiative, seien Sie proaktiv und entfernen oder reduzieren Sie den Geruch, bevor der Kunde zu Ihnen kommt. Das schafft zufriedene Kunden. Auf Seite 19 finden Sie detaillierte Informationen zur Ersten Hilfe gegen Geruch. Siehe auch Abschnitt Tipps & tricks auf den Seiten 40-56. Vaportek ist nicht nur für Erste Hilfe, sondern kann selbstverständlich während des gesamten Sanierungsprozesses angewandt werden.




VAPORTEK – WISSENSCHAFTLICHE FORMEL ZUR GERUCHSNEUTRALISIERUNG! ÄTHERISCHE ÖLE NEUTRALISIEREN DEN SCHLECHTEN GERUCH UND HABEN GLEICHZEITIG EINEN LUFTREINIGENDEN UND ANTISEPTISCHEN EFFEKT.
Die Vaportek-Methode ist keine Maskierung des Geruches, sondern eine Geruchsneutralisierung, basierend auf der Anwendung von zwei Methoden: "Zwaardemaker Pairs" und "Van Der Walls´s Forces". Siehe Seite 16-18.
Vaportek neutralisiert den Geruch mit der Kraft von ätherischen Ölen und besitzt damit auch noch den positiven Nebeneffekt, daß die angwandten Öle gut riechen. Duftet es gut - Ist es SAUBER!

Die meisten Versicherungskunden wissen einen guten Duft nach einem Schaden zu schätzen.
Der Geruchssinn ist direkt mit dem Bereich im Gehirn verbunden, der als limbisches System bezeichnet wird und das Gedächtnis, die Emotionen und das instinktive Verhalten steuert. Wenn es sauber und gut riecht nach der fertigen Sanierung, wird das vom Kunden als positiv empfunden. Das bedeutet positives Branding Ihres Unternehmens und stärkt Ihre Wettbewerbsfähigkeit. Lesen Sie mehr auf Seite 17.
Die Produkte von Vaportek bieten Ihnen viele Möglichkeiten kreativ zu sein, wenn Sie ein Geruchsproblem lösen müssen. Informationen zur Ausschöpfung des vollen Potenzials der Produkte finden Sie im Abschnitt Tipps und Tricks auf den Seiten 40-56.
In den letzten 45 Jahren haben die Dienstleister in der Schadensanierung die natürlichen und kraftvollen Inhaltsstoffe von Vaportek-Produkten verwendet, um nach Brand- und Wasserschäden, Leichenfunden usw. duftende und geruchsneutrale Ergibnisse zu erzielen. Seit nunmehr 20 Jahren als exklusiv Distributor für die Schadensanierer in Europa, wissen wir von NAC Europe, daß VAPORTEK IHREM UNTERNEHMEN ZUFRIEDENE KUNDEN GEBEN WIRD! Das einzige, was zählt, sind zufriedene Kunden. Verwenden Sie Vaportek-Produkte als Ihr vielseitigstes und wichtigstes Werkzeug für Ihre verschiedenen Geruchsbeseitigungsaufgaben und setzen Sie damit die Kundenzufriedenheit an oberste Stelle! Auf den folgenden Seiten erfahren Sie alles über die Technologie, Produkte und die vielen Anwendungsmöglichkeiten von Vaportek.
BASIERT AUF DEN KRÄFTEN DER NATUR!
Die Vaportek-Technologie ist eine einzigartige Methode zur sicheren, effektiven und einfachen Geruchsentfernung. Die Methode hat einen globalen Standard für umweltfreundliche und benutzerfreundliche Geruchsbeseitigung in der Schadensanierung geschaffen.
Eine wissenschaftlich, patentierte Zusammensetzung von mehr als 30 verschiedenen und 100 % natürlichen, aromatischen Pflanzenextrakten ist die Basis der vielseitigen Produktpalette von Vaportek. Diese komplexe Mischung aus ätherischen Ölen heißt Neutrox Gamma und wurde in den späten 70‘er Jahren von einem amerikanischen Pharmahersteller für sichere und wirksame Neutralisation schlechten Geruches im US-Gesundheitssystem entwickelt.
Heute wird Vaportek mit großem Erfolg für viele Aufgaben in verschiedenen Branchen und Industriezweigen angewandt.
EINZIGARTIGE TROCKENDAMPFTECHNOLOGIE
Neutrox Gamma Öl ist hermetisch in einer einzigartigen Kunststoffmembran versiegelt. Der eingebaute Lüfter des VaportekGerätes leitet Luft über die Membran und das Öl diffundiert als Trockendampf in die Luft.
Die Pflanzenölmolekyle des Trockendampfes sind äußerst aktiv und verteilen sich schnell in den gesamten Behandlungsbereich, um auf molekularer Basis effektiv Gerüche von Brand- und Rußschäden, Nikotin, Urin, Schimmel, Abwasser, Fäkalien, angebrannten Speisen, Schweiß, Erbrochenem, Verwesung, Haustiere und anderen Gerüche organischen Ursprungs zu verkapseln und neutralisieren oder geruchsmodifizieren.
Der Trockendampf dringt ein und behandelt effektiv poröse/halbporöse, glatte/harte Oberflächen und Materialien wie z.B. Holz, Beton, Tapete, Putz, Ziegel, Textilien, Kunststoff usw.
Bei Fragen zu den Produkten, Preisen oder dem Rabattsystem können Sie sich gerne an unser Büro unter info@nac-europe.com oder Telefon +45 7442 6292 wenden. Wir sprechen Englisch, Deutsch und Skandinavisch.

Jesper Natorp, Geschäftsführer
VAPORTEK - DAS VIELSEITIGSTE GERUCHSSANIERUNGSKONZEPT
IN DER BRAND- UND WASSERSCHADENSANIERUNG
Heute besteht die Produktpalette von Vaportek aus vielen verschiedenen und völlig einzigartigen Produkten, die auf der natürlichen und patentierten Neutrox Gamma Ölmischung basieren. Die Produkte werden mit großem Erfolg in vielen verschiedenen Branchen und Industriezweigen angewandt.

Ozonfrei
Erste Hilfe bei Geruchsproblemen
Verwenden Sie Vaportek überall und jederzeit
Die Vaportek-Methode ist umweltfreundlich und benutzerfreundlich
Verwenden Sie Vaportek-Produkte vor, während und nach Ihrer Sanierung
Der aktive Trockendampf behandelt gleichzeitig Luft, Hausrat und Gebäude
Vaportek - einfache, schnelle und effektive Geruchsbeseitigung





DIE FOLGENDEN SEITEN GEBEN IHNEN EINEN KURZEN ÜBERBLICK
ÜBER TECHNOLOGIE, VERWENDUNG UND PRODUKTE
• Gegründet 1979.
• Entwickelt für den Einsatz im US-Gesundheitssystem.
• Ein Familienunternehmen.
• Einzigartige und patentierte Technologie auf Basis
•

Vaportek hat seinen Haupsitz in Sussex, Wisconsin, U.S.A.
MIT AKTIVEM TROCKENDAMPF

• Ätherische Öle sind konzentrierte, aromatische Pflanzenextrakte, die aus Blüten, Rinde, Blättern, Früchten und Wurzeln gewonnen werden durch Pressen, Enfleurage dh. Extraktion von ätherischen Ölen durch Fette oder durch Wasserdampfdestillation.
• Patentierte Mischung aus ätherischen Ölen, die in atmungsaktiven Membranen versiegelt sind und einen einzigartigen, geruchsneutralisierenden und aktiven Trockendampf freisetzen.
• Die umweltfreundliche und benutzerfreundliche Alternative zu Ozongeräten, Thermofoggern, ULV-Kaltvernebler oder umweltschädlichen Chemikalien.
• Es ist nicht nur eine "Maskierung" des Geruchs, sondern eine echte Neutralisierung nach der Zwaardemaker PairsMethode. Mehr Info auf Seite 17.
• Neutrox Gamma Öl - Das Original! Einzigartige und komplexe Mischung aus ätherischen Ölen, die für alle Arten von Gerüchen verwendet werden können. Wissenschaftliche Formel. Siehe Seite 36.
• SOS (Smoke Odour Solution) - Einzigartige, komplexe und geniale Mischung ausgewählter ätherischer Öle. Insbesondere für alle Arten von Rauch und Rußgeruch nach Holz-, Papier-, Kunststoff- und Proteinbränden geeignet. Wissenschaftliche Formel. Siehe Seite 37.
• Lemon und Summer Orange zur milden Geruchsneutralisierung und Erfrischung von Räumen. Fresh & Clean Citrus Konzept. Siehe Seite 38-39.




• Zur Geruchsentfernung bei Brand-/Wasserschäden und anderen Schäden, bei denen Geruch entfernt oder kontrolliert werden muss.
• Sicher für den Einsatz im Gesundheitswesen und in Privathaushalten.
• Anwendungsbeispiele:
- Angebrannte Speisen und Essensgeruch (Curry, Fisch usw.).
- Zigaretten- und anderer Tabakgeruch.
- Brand- und Rußschäden.
- Heizölleck.
- Geruch von Schädlingen (Fäkalien, Verwesung).
- Reinigung nach Unfällen, Todesfällen und Leichenfunden.
- Wasserschäden inkl. Schimmel- und Abwasserschäden.
- Umkleidekabinen und andere Gerüche in Sportanlagen.
- Restaurants/Bars mit Rauch und/oder Essensgeruch.
- Geruch in Autos/Wohnwagen/Booten usw.
- Für alle Industrie-/Produktionsbereiche, in denen Geruch ein Problem darstellt.
- Tierheime und Kliniken… und vieles mehr!
Um das beste Ergebnis zu erzielen, ist es wichtig die Geruchsquelle so zu entfernen, daß der Geruch nicht wieder auftritt.
EINZIGARTIG UND UNIVERSELL EINSATZBAR GEGEN ALLE GERÜCHE




• Bei einer Raumtemperatur von 20°C - 30°C wird eine optimale Leistung erzielt.
• Niedrige Raumtemperaturen unter 10°C können die Erzeugung von aktivem Trockendampf bei Patronen und Membranen verringern.
• Die Luftzirkulation hilft bei der Verteilung des Trockendampfes bei grösseren Räumlichkeiten.
Verwenden Sie z.B. einen Luftventilator/Gebläse, um den Trockendampf vom VAPORSHARK schneller im Behandlungsbereich zu verteilen.






Ideal für eine schnelle Geruchskontrolle im Falle von Großschäden, Brand in Kaufhäusern, Werkhallen, Einkaufszentren etc.
• Die einzigartige Ölmischung von Vaportek beinhaltet 100% natürliche, ätherische Öle/Pflanzenextrakte.
• KEIN OZON! – KEIN FOGGING!
• Keine Bedarf für Atemschutz, Sondergenehmigungen oder umfassende Ausbildung.
• Keine Evakuierung/Umsiedlung von Bewohnern/Geschädigten.
• Keine Gefahr beim Wiedereinzug.
• Keine Quarantäne erforderlich.
• Hinweis! Vaporteks Produkte können aufgrund des Inhaltes von natürlichen Inhaltsstoffen, bei empfindlichen Personen eine allergische Reaktion hervorrufen, was jedoch selten auftritt. Wenden Sie sich an NAC Europe. Wir haben auch andere, umweltfreundliche Lösungen, ohne Pflanzenextrakte.




• Hinterlässt KEINE klebrige/fettige Oberfläche.
• Gibt KEINE Feuchtigkeit an die behandelten Bereiche ab.
• Erfordert KEINE Evakuierung des behandelten Bereichs.
• Erfordert KEIN Abschalten von Rauchmeldern oder Elektrizität.
• Erfordert KEINE Verwendung eines Atemschutzgeräts.
• Erfordert KEINE spezielle Schulung oder Genehmigung.
• Es besteht KEINE Gefahr von Entzündung/Explosion (z.B. im Zusammenhang mit Gasbrennern/Rauchen).
• Erfordert KEINE Entfernung von Pflanzen, elektronischen Geräten usw.

AKTIVER TROCKENDAMPF VON VAPORTEK
• Kann sicher in allen bewohnten Räumlichkeiten angewandt werden.
• Erfordert keine Evakuierung/Entfernung von Bewohnern, Pflanzen und Haustieren.
• Sicherer Aufenthalt in den behandelten Räumlichkeiten während und nach der Behandlung.
• KEINE Oxidation oder Bleichung von Materialien und Oberflächen.
• KEINE Beschädigung von Naturgummi (Latex), Textilien, Leder, Klebstoffe, PVC oder anderen Materialien.
• Kann in feuchter Umgebung verwendet werden.
• Bildet keine schädlichen Nebenprodukte.
• Schnellere Behandlung/Wirkung.
• Der Restorator und Vaporshark bieten Ihnen viele Jahre mühelosen Betrieb mit geringem Stromverbrauch und ohne Austausch von UV-Lampen.
• Behandelt Räume bis 2.500 m3 und größer, je nach Art und Intensität des Geruchs.
• Verwenden Sie 1-3 Membranen.
• Die Membranen sind als Neutrox Gamma, SOS (Smoke Odour Solution), Summer Orange und Lemon erhältlich.
• Die Lebensdauer der Membranen beträgt ca. 200-300 Stunden.
• Solides, leichtes Aluminiumgehäuse.
• Grösse: 40,5 x 20,5 x 43 cm. Gewicht 5,9 kg.
• 220 V - eingebauter Ventilator 1,5 m3/min.
• Beliebt in der Brand- und Wasserschadenssanierung. Schnelle Erste Hilfe bei plötzlich entstandenen Geruchsproblemen. Siehe Seite 19.
Lesen Sie mehr über den Vaporshark auf den Seiten 20-21 und 54-56.
• Einfach zu bedienendes, kompaktes Elektrogerät.
• Behandelt Räume bis 600 m3, je nach Art und Intensität des Geruchs.
• Verwendet austauschbare Patronen.
• Patronen sind in Neutrox Gamma, SOS (Smoke Odour Solution), Lemon, Summer Orange und anderen Duftvarianten erhältlich.
• Die Lebensdauer der Patrone beträgt ca. 200-300 Stunden.
• Der kleine, aber leistungsstarke Ventilator verteilt den Trockendampf schnell und leise.
• Ideal zur Schadensanierung, Hotelzimmer, Fahrzeuge und viele andere Verwendungszwecke.
• Grösse: 16 x 13 x 30 cm. Gewicht 1,7 kg.
Weitere Informationen zum Restorator finden Sie auf den Seiten 22-23 und 52-53.

LESEN SIE MEHR ÜBER
DEN VAPORSHARK
AUF DEN SEITEN 20-21
ZU BELIEBTEN ANWENDUNGEN
SEITE 54-56


LESEN SIE MEHR ÜBER
DEN RESTORATOR AUF DEN SEITEN 22-23
ZU BELIEBTEN ANWENDUNGEN
SEITE 52-53







neutrox gamma oil
• Neutrox Gamma Bricks geben einen unschädlichen Trockendampf auf Basis ätherischer Öle ab.
• Der Trockendampf besteht aus einer komplexen Zusammensetzung von über 30 verschiedenen, 100% natürlichen Pflanzenextrakten.
• Der Trockendampf breitet sich schnell in der Luft aus, um die Geruchsmolekyle zu verkapseln und zu neutralisieren. z.B. bei Rauch und Brandschäden, Wasserschäden, Abwässerschäden, Schädlinge, Trockenkochen, Trockenbraten, Speisedunst, verschüttete Chemikalien, Verwesung, Schimmel, Moder, Abfall, Schweiß, Urin, Erbrochenem, Tiere u.a.
• Kann auch vorteilhaft in Entfeuchtung - und Lüftungsgeräten zur Luftreinigung und Geruchskontrolle eingesetzt werden.
Weitere Informationen zu Neutrox Gamma Bricks finden Sie auf den Seiten 26-29 und 40-45.
• Aroma Bricks ist in Form, Struktur und Funktionsweise identisch mit Neutrox Gamma Bricks, basiert jedoch auf 6 exquisiten Duftvarianten, die alle den Geruchssinn beleben.
• Aroma Bricks verströmen einen Duft in den zu behandelnen Raum, der den imaginären Restgeruch unterdrückt. Restgeruch kann von Geschädigten z.B. nach einem Brand empfunden werden, obwohl kein Geruch mehr vorhanden ist.
• Ihre Kunden werden zufrieden sein.
• Kann auch vorteilhaft in Lüftungs- Entfeuchtungs- und Luftreinigungsgeräten zur Entfeuchtung und Geruchskontrolle eingesetzt werden.
• Aroma Bricks können auch in Staubsaugern verwendet werden und sind auch im Zusammenhang mit der Sanierung von Hausrat beliebt. Nutzen Sie Ihre Vorstellungskraft!
• Aroma Bricks Duftvarianten: Lemon, Summer Orange, Ocean, Berry, Linen und Cool Green.
Weitere Informationen zu Aroma Bricks finden Sie auf den Seiten 26-29 und 40-45.
LESEN SIE MEHR ÜBER NEUTROX GAMMA- UND AROMA BRICKS AUF DEN SEITEN 26-29
ZU BELIEBTEN ANWENDUNGEN
SEITE 40-45



BRICKS GIBT ES JEZTZ AUCH MIT SOS ÖL
BESTSELLER SCHADENSANIERUNG










ECOZ GERUCHSNEUTRALISATOR-KONZENTRAT

• Speziell entwickelt zur Geruchsentfernung bei der Reinigung von Oberflächen nach Brandschäden usw.
• Zur Verwendung auf Böden, Wänden und anderen Oberflächen. Kann jeder duftneutralen Reinigerlösung oder dem Wasch-/Spülwasser bei gemischt werden.
• Die beliebten ECOZ-Konzentrate von Vaportek sind wassermischbare Mikroemulsionen aus ätherischen Ölen. Es ist wissenschaftlich bewiesen, daß natürliche ätherische Öle die Fähigkeit besitzen Gerüche zu neutralisieren. ECOZ ist eines der wenigen Produkte auf dem Markt, das echte ätherische Öle enthält.
• Biologisch abbaubar, benutzerfreundlich, nicht ätzend, hinterlässt keine Rückstände oder fettige Oberflächen.
• Erhältlich in den Aromen: Classic Neutral, SOS, Lemon, Summer Orange und Linen.
Weitere Informationen zu ECOZ finden Sie auf den Seiten 30-31 und 46-49.
BIO-C (KONZENTRAT – BIOL. GERUCHSNEUTRALISATOR)
• Bioenzymatisches, wassermischbares Konzentrat für Geruchsneutralisierung und Zersetzung von organischem Material.
• Spezialprodukt von VAPORTEK bestehend aus einer komplexen Mischung von über 30 verschiedenen ätherischen Ölen (100% natürliche Pflanzenextrakte) und eine Suspension von Mikroorganismen, sowie Enzymen.
• Bio-C fördert und beschleunigt den natürlichen Abbauprozess durch Anwendung einer starken Mischung aus speziellen Bakterienkulturen und einer Mischung aus Lipase, Cellulase, Protease und Amylaseenzymen.
• Entfernung und Abbau von Gerüchen von Fäkalien, Verwesung, Urin, Rauch, Fettabscheider, Erbrochenem, Feuchtigkeit, Schimmel, Schweiß, Tiere, Hausmüll und andere Gerüche biologischer/organischer Herkunft.
Weitere Informationen zu Bio-C finden Sie auf den Seiten 32-33 und 50-51.

LESEN SIE MEHR ÜBER ECOZ AUF DEN SEITEN 30-31
ZU BELIEBTEN ANWENDUNGEN

SEITE 46-49

BESTSELLER SCHADENSANIERUNG



LESEN SIE MEHR ÜBER BIO-C AUF DEN SEITEN 32-33
ZU BELIEBTEN ANWENDUNGEN
SEITE 50-51
BIO-C ENTFERNT BIOLOGISCHEN/ ORGANISCHEN GERUCH






• Enthält eine Membran - zur Behandlung von Räumen bis zu 700 m3 und mehreren 1000 m3 wenn in Lüftungskanälen platziert.
• Kann vor einem Luftgebläse verwendet werden oder platziert in Lüftungssystemen, Entfeuchtungssystemen usw.
• Verfügbar in dem Duftvarianten Neutrox Gamma, SOS, Lemon oder Summer Orange.
• Der Alu-Drehverschluss an den Enden ermöglicht die Einstellung der Trockendampfintensität. Mit dem AluDrehverschluss schließen und zur späteren Verwendung aufbewahren. Kann mit Ständer/Stabilisator geliefert werden.
• Die Betriebsdauer beträgt ca. 250-300 Stunden.
• Maße: 14,6 cm x 9,5 cm Durchmesser. Wiegt weniger als 500 g.
Weitere Informationen finden Sie auf den Seiten 34-35.
• Nature Fresh ist ein zylinderförmiges, passives Trockendampf-System in zwei Größen.
• Nicht elektrisch. Drehen Sie einfach das verstellbare Ober- oder Unterteil um den Luftstrom zu steuern.
• Ideal für Bereiche, die durchgehend belüftet werden müssen, wo die Geruchsquelle nicht entfernt werden kann.
• Für bewohnte Räumlichkeiten und Anwendungen im Pflegesektor, Krankenhaus, Industrie, Tierkliniken, Fitnesscenter usw.
• Schadensanierung - kann im Zusammenhang mit dem Austrocknen von Gebäuden usw. in Entfeuchtungssystemen platziert werden.
• Wird mit Neutrox Gamma Papiermembranen geliefert.
• Neutrox Gamma Bricks und Aroma Bricks können auch eingesetzt werden.
Warennummer:
56-1302 Kleine Version
56-1303 Große Version
-
SICHER - EFFEKTIV

LESEN SIE MEHR ÜBER
DIE HDS PATRONE
AUF DEN SEITEN 34-35
ZU BELIEBTEN ANWENDUNGEN
SEITE 34-35


KONTAKTIEREN SIE UNS FÜR MEHR INFORMATIONEN ÜBER NATURE FRESH

Kette mit zwei Clips zum Aufhängen von Neutrox Gamma Bricks, SOS Bricks, Aroma Bricks oder EZ-Disk.


Artikelnummer 56-1345 Krokodilklemme (einfaches Klipssystem)
an Wände, Türen und dergleichen aufgehängt. EZ-Twist setzt Trockendampf frei, ohne Verwendung von Batterien. Die Trockendampfintensität wird durch Drehen des Deckels des EZ-Twists eingestellt.
EZ-Twist verwendet EZ-Disk (siehe Seite 15). Einzigartiger Trockendampf - Keine Aerosole oder Gelees.
TIPP!
Kann auch mit Neutrox Gamma Bricks und Aroma Bricks verwendet werden. Die Bricks werden mit einem Messer halbiert und die 2 Hälften werden auf je eine Seite vom Mittelstift gelegt. Siehe Bild.
Artikelnummer 21-7601 EZ-Twist Tüte mit 12 Stck. Lieferung in Tüten mit 12 Stück.

KONTAKTIEREN SIE UNS FÜR MEHR INFORMATION ÜBER VERSCHIEDENE LUFTGEBLÄSE
ZU BELIEBTEN ANWENDUNGEN
SEITE 40-45

KONTAKTIEREN SIE UNS FÜR MEHR EZ-TWIST-INFORMATION






EZ-Disk ist eine spezielle Papierfaserscheibe (Cellulose), gesättigt mit natürlichen, aromatischen Ölen.
Wird in EZ-Twist und Vaportronic angewendet. Neutrox Gamma Bricks und Aroma Bricks können auch im Vaportronic verwendet werden. Siehe Bild rechts.
Artikelnummer 56-1227 Vaportronic Aromadispenser
Artikelnummer in folgenden Aromen erhältlich: (Tüte mit 12 Stck.)
56-1323 Neutral/Neutrox Gamma Öl
56-1939 Ocean
56-1955 Summer Orange
56-1322 Lemon
56-1321 Potpourri
56-1339 Berry
56-1338 Orchard - Früchte
56-1913 Cool Green
Wir empfehlen Aroma Bricks in Vaportronic. Preisersparnis gegenüber EZ-Disk.
• Einfach zu bedienendes, kompaktes Elektrogerät.
• Geeignet für dauerhafte Installation gegen anhaltende/ dauerhafte Geruchsbelästigung.
• Einstellbare Stärke.
• Behandelt Räume bis zu 600 m3 je nach Art und Intensität des Geruchs.
• Verwendet austauschbare Optimum 4000-Patronen: Erhältlich in Neutrox Gamma, SOS (Smoke odour Solution) Lemon, Summer Orange und anderen Duftvarianten.
• Die Lebensdauer der Patrone beträgt ca. 3-5 Monate. Geräuscharmer Betrieb.
• Stabile Konstruktion mit vinylbeschichtetem Stahlgehäuse mit Kunststoffdeckeln an beiden Enden.
• Maße: H x B x L = 13 x 13 x 30 cm. Gewicht ca. 2 kg.
• Für Umkleidekabinen, Hotel-/Empfangsbereiche, Krankenhäuser, Hospize/Pflegeheime, Tierkliniken, Zwinger, Gefängnisse, Büroumgebungen, Turnhallen usw.
Weitere Informationen finden Sie auf Seite 24-25.
SCHNELL - VIELSEITIG
SICHER - EFFEKTIV

KONTAKTIEREN SIE UNS FÜR MEHR INFORMATION ÜBER
EZ-DISK UND VAPORTRONIC




LESEN SIE MEHR ÜBER OPTIMUM 4000 AUF DEN SEITEN 24-25




VAN DER WAALS KRAFT:
Dies bezieht sich auf die interaktive Energie, die zwischen Stoffen von außerordentlich geringer Größe stattfindet. Es sind Kräfte, die bei Kollision, Abstoßung und Anziehung enstehen und die das Verhalten nicht elektrisch geladener Teilchen in gasförmiger Form steuern. Dies erklärt die Anziehungskraft zwischen ätherischen Ölen und den Geruchsstoffen, wenn diese in einem Dampfzustand sind.
ZWAARDEMAKER PAIRS:
ÄTHERISCHES ÖL MOLEKYLE
(z.B. Wacholderbeerenöl)
DUFT MOLEKYLE
(z.B. Buttersäure)
Zwaardemaker Pairs basiert auf einer wissenschaftlichen Entdeckung. Wenn man bestimmte ätherische Öle und übelriechende Substanzen in "spezifischen Paaren" kombiniert, entsteht kein Geruch. Die Geruchintensitet der Mischung wird deutlich geringer als die der beiden einzelnen Gerüche. Diese Wechselwirkung von Geruchsstoffen und Ölen ist ein Phänomen das Ende des 19. Jahrhunderts vom flämischen Wissenschaftler Hendrik Zwaardemaker entdeckt wurde.
VERBESSERN
SIE DAS IMAGE IHRES UNTERNEHMENS DURCH DAS HINZUFÜGEN EINES DISKRETEN UND POSITIVEN DUFTES, AN DEN SICH IHR KUNDE ERINNERN WIRD!
Es ist wissenschaftlich erwiesen, daß wir Menschen stark emotional von unserem Geruchsinn gesteuert sind. Nach unserem Sehsinn ist der Geruchssinn der, der den größten Einfluss auf den Menschen hat. Stellen Sie sich vor, Sie könnten durch den guten Duft ein kleines Extra für Ihre Kunden erzielen und damit in guter Erinnerung bleiben.




Es ist wissenschaftlich erwiesen, daß wir Menschen weitgehend emotional von unserem Geruchssinn kontrolliert werden. Nach dem Sehsinn ist der Geruchssinn einer unserer Sinne, der den größten Einfluss auf die Menschen hat.
MENSCHEN LIEBEN GUTEN DUFT!
Vaportek’s Spezialöle und Konzentrate basieren auf 100% natürlichen und sehr wirksam duftenden, ätherischen Ölen, die seit 45 Jahren weltweit überzeugende Ergebnisse in der Geruchsbeseitigung in der professionellen Schadensanierung erzielt haben. Es ist wissenschaftlich erwiesen, daß natürliche ätherische Öle die Fähigkeit besitzen Gerüche zu neutralisieren. Die Technologie von Vaportek ist keine Maskierung des schlechten Geruches. Vaportek funktioniert auf einer wissenschaftlich bewährten Methode, namens "Zwaardemaker Smell System" oder "Zwaardemaker Pairs".
Die Technologie von Vaportek basiert auf Studien und Forschungen von: Hendrik Zwaardemaker Geboren am 10. Mai 1857, Haarlem. Gestorben am 19. September 1930, Utrecht. Nationalität: Niederländisch Professor für Experimentelle Physiologie an der "University of Utrecht". Sein Hauptwerk war: "Physiologie of Olfaction", veröffentlicht 1895.

KEINE MASKIERUNG, SONDERN EINE
NEUTRALISIERUNG DES GERUCHES
Ein wichtiger Beitrag von Zwaardemakers Studien ist das Konzept von Geruchskonjugation. Zwaardemaker entdeckte, daß bestimmte Gerüche vom Geruchssinn nicht wahrgenommen wurden, wenn sie mit verschiedenen ätherischen Ölen gemischt werden. Diese Kombination von ätherischen Ölen und Gerüchen werden als "Zwaardemaker Pairs" (oder Z-Paare) bezeichnet.
SCHLECHTER GERUCH GERUCHSQUELLEN Z-PAIR ÄTHERISCHE ÖLE WIRKSTOFF
Buttersäure
Erbrochenes, Verwesung, saure Milchprodukte WACHHOLDER BEEREN-ÖL
Chlor VANILLE VANILLE
Ammoniak Urin ROSEN-ÖL IONONE
Tabak Zigarettenrauch WINTERGREEN ÖL METHYLSALICYLAT
Moskus BITTER MANDEL ÖL BENZALDEHYD
Gummi ZEDERHOLZ-ÖL
Skatol Fäkalien ZEDERHOLZ-ÖL
Mercaptan Naturgas EUKALYPTUS ÖL EUCALYPTOL
RIECHT ES GUT? DANN IST ES SAUBER!
Die Produkte von Vaportek neutralisieren Gerüche durch die Wirkung der feinen ätherischen Öle, die nach der Zwaardemaker Pairs-Methode arbeiten. Seit 1895, wo Hendrik Zwaardemaker seine ersten Studien präsentierte, ist viel passiert. Jack Bryson, der Gründer Vaporteks, hat einen grossen Verdienst geschaffen, daß die Möglichkeiten von ätherischen Ölen voll ausgeschöpft wurden. Auf dieser Basis hat er ein Unternehmen auf die Beine gestellt mit Produkten, die großen Respekt in der Schadensanierung und in anderen Branchen geniessen. Die Dienstleister in der Schadensanierung haben seit 45 Jahren Vaportek‘s natürliche Inhaltsstoffe angewandt um duftende oder geruchneutrale Räume nach Brandschäden, Abwasserschäden, Leichenfunden usw. zu schaffen.
Räumlichkeiten/Einrichtungen, die mit Vaportek's Produkten behandelt wurden, werden nicht mit einem Duft maskiert. Die Zimmer/Einrichtungen sind frisch und duftend – was der menschliche Geruchssinn als sehr positiv wahrnimmt.
Die Geschädigten kehren in ein geruchloses Haus zurück und sie geniessen z.B. den frischen Zitrusduft von Vaportek... DAS IST VAPORTEK !
Viele Versicherungskunden, die einen Brandschaden oder andere Schäden hatten, wo das Schadensanierungsunternehmen die Vaportek Produkte angewendet hat, kontaktieren uns um unsere Produkte in ihrem Alltag zur Behandlung von Gerüchen von Haustieren, Tabakrauch, Essensgeruch usw. zu verwenden.
In anderen Situationen kann es wünschenswert sein, völlig geruchneutrale Räume zu schaffen. Auch das kann NAC Europe für Sie machen. Wir bieten ein komplettes Pro gramm von High-Tech-Produkten an, die mit Oxidation arbeiten. Diese können separat ver wendet werden oder in Kombination mit Vaportek. Das nennen wir "Das Beste aus zwei Welten". Diese Konzepte werden im neuen "GeruchsmanagementKonzept" von NAC vorgestellt. Weitere Informationen finden Sie auf Seite 59.

Wir werden oft gefragt, ob Vaporteks Technologie nur maskiert oder wirklich schlechte Gerüche beseitigt.
Die Antwort lautet: Vaportek beseitigt organische Gerüche!
GERUCHSMASKIERUNG CONTRA GERUCHSNEUTRALISIERUNG
Maskieren bedeutet, die Gesamtgeruchsintensität zu erhöhen um schlechten Geruch zu überdecken. Das bedeutet, Einführung eines neuen Geruchs, der stärker riecht als der schlechte Geruch, den man entfernen möchte. Das Resultat ist eine Bombardierung von wahrgenommenen Gerüchen, die nichts mit der Entfernung der Quelle des ursprünglichen schlechten Geruches zu tun hat.
Neutralisieren heißt, übelriechende Moleküle auf molekularer Ebene durch direkte Gegenmaßnahmen mit einer zusätzlichen Verbindung, in diesem Fall Vaporteks einzigartige Mischung aus reinen ätherischen Ölen, zu eliminieren oder auf molekularer Ebene nicht wahrnehmbar zu machen. Die übelriechenden Moleküle werden via einer chemischen Interaktion, die als Geruchspaarung oder Einkapselung bezeichnet wird (siehe auch Zwaardemaker Pairs Seite 16-17) zu einer neuen molekularen Form gestaltet, so daß es entweder nicht mehr riecht oder der Geruch so flüchtig ist, daß er nicht mehr wahrgenommen wird. Auf diese Weise wird das übelriechende Molekül reduziert, in dem es verschwindet, da es zur Unkenntlichkeit zerlegt wurde.
Wenn die ätherischen Ölmischungen von Vaportek als Trockendampf in die Luft abgegeben werden, reagieren sie direkt mit übelriechenden Molekülen in der Luft. Diese molekulare, chemische Interaktion ermöglicht es, daß die Produkte von Vaportek wirksam den Geruch biologischen Ursprunges neutralisieren.
WARUM ÄTHERISCHE ÖLE?
Der Grund, warum Vaportek einen zusätzlichen Duft hinzufügt (der missverständlich als Maskierung aufgefasst wird), ist auf Vaporteks komplexe Formel, bestehend aus reinen ätherischen Ölen und der präzisen Komplexität der Ölformel zurückzuführen, die damit einen Schritt weiter geht und effizienter ist. Vaportek entfernt damit die Quelle der übelriechenden Moleküle durch Einkapselung und Geruchspaarung (Zwaardemaker Pairs). Obwohl es eine große Anzahl von ätherischen Ölen gibt, sind nicht alle in der Lage organische Gerüche wie Rauch, Urin, Verwesung oder Schimmel usw. zu neutralisieren.
Vaportek hat die richtige Mischung sorgfältig ausgewählter Öle, die für eine effektive und dauerhafte Geruchsentfernung notwendig sind, formuliert. Deshalb ist die Technologie von Vaportek so einzigartig. Unsere ätherischen Ölmischungen ermöglichen es, eine breite Palette von Geruchsstoffen wie Aldehyd, Amin, Diamin, Sulfid, Lacton, Carbonsäure, Ester, Carbylamine, Keton, Skatole, Mecaptan und andere Kohlenstoffe zu neutralisieren. Es ist den ätherischen Ölmischungen von Vaportek zu verdanken, daß Vaportek stolz darauf sein kann, seinen Kunden eine umwelt-
Verwenden

freundliche Lösung für ihre Geruchsprobleme, anbieten zu können anstatt gezwungen zu sein Chemikalien und Ozon produzierende Maschinen zu verwenden. Viele vorhandene Geruchsbeseitigungslösungen sind schädlich für sowohl Anwohner, Geschädigte als auch Fachkräfte, die eine solche Ausrüstung verwenden müssen. Das kann zu Atemwegserkrankungen und Lungenschäden führen. Ozonmaschinen etc. können auch der Umwelt schaden. Die Vaportek-Technologie ist FCKW-frei, ungiftig und VOC-konform.
WARUM TROCKENDAMPF?
Vaportek unterscheidet sich desweiteren von seinen Mitbewerbern in Bezug auf Diffusionstechnik bei der Anwendung von Trockendampf, der keine Feuchtigkeit in den Behandlungsbereich abgibt. Man kann den Trockendampf nicht merken, nur den guten Duft von ätherischen Ölen.
Die Vaportek-Trockendampftechnologie erzeugt kein schädliches Ozon oder Hydroxyl und erfordert keine Anwendung von ULV Kaltverneblern oder Thermofoggern. Der Vaportek-Trockendampf besitzt eine hohe Luftmobilität und ist in der Lage poröse Materialien, wie Gipsplatten, Holz, Teppiche, Zement, Ziegel, Isolierung und andere Oberflächen sicher zu durchdringen. Diese Technologie ist einzigartig.
VERTRAUEN SIE AUF VAPORTEK
Vaportek ist das Unternehmen hinter der bahnbrechenden Trockendampftechnologie, welches auf einzigartigen ätherischen Ölen basiert. Vaportek hat Erfahrung seit 1979 und viele Firmen versuchen unsere Produkt zu kopieren. Vertrauen Sie Vaportek und dem Unternehmen und wir garantieren eine effektive und dauerhafte Geruchsentfernung.
ENTFERNEN SIE ORGANISCHEN GERUCH
Hier einige Beispiele für Gerüche organischen Ursprungs, die Vaportek-Produkte wirksam neutralisieren können:
Rauch, Nikotin, Urin, Schweiß, Erbrochenes, Essensgeruch, Lebensmittelgeruch, Schimmel, Feuchtigkeit, Ruß-/Rauchgeruch nach Brand, Verwesung und vieles mehr.




ES GIBT VIELE GUTE GRÜNDE, VAPORTEK-PRODUKTE ZU VERWENDEN - HIER IST EINER VON IHNEN!
BEI PLÖTZLICH AUFTRETENDEN GERUCHSPROBLEMEN GEHT ES DARUM, PROAKTIV ZU SEIN, SCHNELL ZU REAGIEREN UND DADURCH ZUFRIEDENE KUNDEN ZU BEKOMMEN
Außer der Tatsache, daß sich Vaporteks einzigartige Technologie und Produkte in den letzten 45 Jahren bei den globalen Schadensanierungsunternehmen bewährt haben und heute beliebte Produkte zur vollständigen und dauerhaften Geruchsentfernung während des gesamten Sanierungsprozesses sind, zeichnen sie sich vor allem durch ihre Vielseitigkeit und besonders schnelle Wirkung bei plötzlich entstehenden Geruchsproblemen aus.

Hier bieten Vaportek-Produkte eine sehr schnelle und wirksame Erste Hilfe gegen Gerüche, was bedeutet, daß Beschwerden und Belästigungen über z.B. Rauch-Ruß-Geruch nach Brand in Privathäusern, Apartmentkomplexen, Unternehmen, Treppenhäusern, Einkaufszentren, Produktionsräumen usw. vollständig verhindert werden können, wenn eines oder mehrere der beliebten und schnell wirkenden Vaportek-Produkte wie z.B. VaporShark, Restorator oder die beliebten Neutrox Gamma, SOS oder Aroma Bricks verwendet werden

Ergebnis = Zufriedene Kunden, die das Geruchsproblem hier und jetzt gelöst bekommen. Ihre Firma ist proaktiv und Ihre schnellen Bemühungen werden in Erinnerung bleiben. Das stärkt das Image Ihres Unternehmens!
Erfahren Sie, wie Sie mit Vaportek-Produkten Erste Hilfe leisten können unter dem Abschnitt Tipps & tricks auf den Seiten 40-56
Empfohlene Behandlung bei plötzlichem auftretendem oder anhalten dem Geruch. Extrem sichere und wirksame Geruchsentfernung.
• Kein Ozon.
• Beliebt bei Reinigungs- und Schadensanierungsunternehmen weltweit.
• Sofortige Ergebnisse ohne gesundheitliche Risiken.
• Schnelle Geruchsentfernung fördert die Kundenzufriedenheit.
• Die Geruchsentfernung ist dauerhaft bei schwierigen Gerüchen.
• Empfohlen von der Versicherungsbranche.
SOS (Smoke Odour Solution) oder Neutrox Gamma Öl kann zur Behandlung von allen Arten von Rauchgeruch nach synthetischen Bränden, Holz und Papierbränden, Proteinbränden usw. verwendet werden.
Installieren Sie das Gerät am Anfang von Sanierungsarbeiten für sofortige Geruchreduzierung für Mitarbeiter und Bewohner.
Sicher für den Einsatz in bewohnten Bereichen während der Sanierung. Vereinfacht und beschleunigt die Reinigung.

Gerüche bei Wasserschäden und Feuchtigkeitsschäden werden effektiv entfernt während der Trocknung. Verwenden Sie z.B. Neutrox Gamma Bricks in Kondensoder Adsorptionstrocknern.
Auch Tiergerüche können entfernt werden und auch Gerüche bei Verwesung usw.
LEISTUNGSFÄHIGES, EFFIZIENTES UND VIELSEITIGES GERUCHSBESEITIGUNGSGERÄT, DASS VAPORTEKS EINZIGARTIGEN, AKTIVEN TROCKENDAMPF PRODUZIERT
– DIE UMWELTFREUNDLICHE ALTERNATIVE ZUR OZONBEHANDLUNG
PRODUKTINFORMATION
Absolut einzigartiges und äußerst effektives Gerät zur dauerhaften Entfernung schlechten Geruches. Hinterlässt die behandelten Räume mit einem reinen, frischen und natürlichen Duft. Eine ausgezeichnete und umweltfreundliche Alternative zur Ozonisierung und Feucht-/Trockennebelerzeugung.
Der VaporShark ist ein tragbares, elektrisches Gerät, das eine unschädliche Technologie verwendet, die schlechte Gerüche schnell, effektiv und dauerhaft entfernt und die Luft in Innenräumen erneuert. Der Vaporshark verwendet das von Vaportek patentierte Membransystem, das eine komplexe Mischung aus über 30 verschiedenen und 100% rein natürlichen, ätherischen Ölen enthält, das heißt ausgepresste und in anderer Weise gewonnene Extrakte aus dem Pflanzenreich, wie z.B. Eukalyptus, Zedernholz, Pfefferminz, Kampfer, Kiefer, Lavendel, Zitrusfrüchte u.v.m.
Wenn der eingebaute Ventilator des Vaporsharks Luft über die Membran führt, öffnet sich die Membran und Öl wird als Trockendampf an die Luft freigegeben. Die Pflanzenölmoleküle des Trockendampfes sind extrem aktiv und breiten sich schnell im gesamten Bahandlungbereich aus und durchdringen effektiv poröse Oberflächen wie z.B. Holz, Beton, Tapeten, Gips, Ziegel, Dämmstoffe, Textilien usw. um schnell und effizient via molekularem Einkapseln und Geruchspaarung (siehe Seite 16-18) die Geruchsbelästigungen von Brand- und Rußschäden, Nikotin, Urin, Abwasser, Fäkalien, angebrannte Speisen, Schweiß, Erbrochenem, Schimmel, Verwesung, Tiere und andere Gerüche organischen Ursprungs zu beseitigen. Auch auf nicht porösen Oberflächen arbeitet der Trockendampf schnell und effektiv.


Lufteinlaß
Verstellbarer Dämpfer
Netzschalter
Luftauslaß
1,8 m Kabel (Erde)

SEITE 54-56
ANWENDUNGEN

Getestet und erprobt von Sanierungsfirmen weltweit für Geruchsneutralisation bei Brandschäden (Protein-, Holz-/Papier- oder synthetischen Brände), Wasserschäden aller Art, Fäkalschäden, Verwesung, Chemikalienschäden, Schwelbrand u.v.m.
Stromverbrauch: 36 Watt
50/60 Hertz 230 V 90 m3/h Gebläse
Luftauslaß (Trockendampf)
Membranstativ mit Membran
Solides Aluminiumgehäuse
Griff für den einfachen Transport
Verschluß

Lufteinlaß




LEISTUNGSFÄHIGES, EFFIZIENTES UND VIELSEITIGES GERUCHSBESEITIGUNGSGERÄT, DASS VAPORTEKS EINZIGARTIGEN, AKTIVEN TROCKENDAMPF PRODUZIERT
UMWELTGERECHTE TECHNOLOGIE
Die Vaportek Technologie basiert auf natürlichen Pflanzenextrakten und ist nicht gesundheitsgefährdend, und deshalb eine bessere Wahl als die Verwendung von Ozongeräten oder Trocken- und Feuchtnebelerzeugung. Im Gegensatz zur Ozonisierung, beschädigt der Vaporshark keine Textilien, Gummi, Kunststoffe, Klebemittel usw. Es wird keine Feuchtigkeit an den behandelten Raum abgegeben und deshalb wird das Risiko für Schäden eliminiert. Da die Methode für Menschen ungefährlich ist, müssen die Räume, die mit dem Vaporshark behandelt werden, nicht evakuiert werden. Die Räume sind während der Behandlung weiterhin nutzbar.
Dieses sehr vielseitige Luftbehandlungsgerät ist für grössere Raumvolumen geeignet, wo ein schnelles Ergebnis erforderlich ist. Raumvolumen bis zu 2.500 m3 abhängig von Geruchsart und Geruchsintensität.
VAPORSHARK Art.-Nr. 56-1229
VAPORTEK MEMBRANEN SIND IN DEN FOLGENDEN ÖLEN VERFÜGBAR
56-1352 Membran - Neutrox Gamma
56-1766 Membran - SOS
56-1758 Membran - Lemon
56-1757 Membran - Summer Orange
VAPORSHARK BEHANDELT LUFT, HAUSRAT UND GEBÄUDE GLEICHZEITIG.
VAPORSHARK'S EINFACHES UND ROBUSTES DESIGN BEDEUTET VIELE JAHRE PROBLEMFREIER BETRIEB OHNE WARTUNGKOSTEN UND MIT MINIMALEM STROMVERBRAUCH - "JUST PLUG AND PLAY"
HINWEIS!
• Dieses System ist eine sichere und effektive Alternative zu Ozonisierung, ULV-Feucht-/Trockennebelerzeugung.
• Keine Gesundheitsrisiken.
• Die Verwendung persönlicher Schutzausrüstung, z.B. Maske ist nicht erforderlich.





AUSGEWÄHLTE SPEZIFIKATIONEN
• Behandelt Raumvolumen bis zu 2.500 m³ und mehr.
• Starke Leichtgewicht Aluminium-Konstruktion
• Maße: 40,5 cm x 20,5 cm x 43 cm.
• Gewicht: 5 kg.
• Membran, die im VaporShark eingesetzt wird und einen aktiven, geruchsneutralisierender Trockendampf freisetzt.
• Stromverbrauch: 36 Watt.
• Die Lebensdauer der Membranen beträgt ca. 200-300 Stunden.
ANWENDUNGSGEBIETE FÜR VAPORSHARK
• Schadenssanierung.
• Lebensmittelproduktion.
• Schlachthöfe.
• Behandlung organischer Abfälle.
• Tierinternate.
• Große Gewächshäuser.
• Abwassersysteme und Kläranlagen.
• Abzugshauben in der Lebensmittelproduktion/ Restaurants usw.
• Große Säle und Tagungsräume.
• Hotels/Messe usw.
• Reinigungsunternehmen und viele andere Branchen.





OZON- UND AEROSOLFREIE METHODE = MAXIMALE SICHERHEIT FÜR BENUTZER Tipp: Verwenden Sie ECOZ Geruchsbeseitigungskonzentrat in Ihrem Wasch-/Spülwasser beim Reinigen nach Brandschäden.

KOMPAKTES, EFFIZIENTES UND VIELSEITIGES GERUCHSBESEITIGUNGSGERÄT – EINFACH ZU BEDIENEN.
DER RESTORATOR PRODUZIERT VAPORTEKS EINZIGARTIGEN AKTIVEN TROCKENDAMPF
- DIE UMWELTFREUNDLICHE ALTERNATIVE ZUR OZONBEHANDLUNG
Gebrauchsanweisung
Besonder kräftiger Haltegriff
Stromschalter
Auslaß von aktivem, geruchsneutralisierenden Trockendampf
Galvanisiertes Stahlgitter
Öffnung zum Einsetzen von Patronen mit Öl

Inwendiges 220 Volt Gebläse, Kapacitet bis zu 1,4 m³ pr. Minute

Stromverbrauch: 11 Watt
ZU BELIEBTEN ANWENDUNGEN
SEITE 52-53


Lufteinlaß Plastikschnur für Deckel

DER RESTORATOR BEHANDELT LUFT, GEGENSTÄNDE/HAUSRAT UND GEBÄUDE GLEICHZEITIG
HINWEIS!
• Dieses System ist eine sichere und effektive Alternative zu Ozonisierung, ULV-Feucht-/Trockennebelerzeugung.
• Keine Gesundheitsrisiken.
• Die Verwendung von persönlicher Schutzausrüstung ist nicht erforderlich.
180 cm Strom-Kabel für 220 Volt Wechselstrom
Robustes vinylbekleidetes 2,2 mm Stahlgehäuse
Patrone mit aktivem Öl zur Geruchsbehandlung (seperat erhältlich)

RESTORATOR Art.-Nr. 56-1226

RESTORATORPATRONEN SIND IN DEN FOLGENDEN ÖLEN VERFÜGBAR:
56-1387 Standardpatrone für Restorator/Optimum 4000 - Neutrox Gamma
56-1769 Standardpatrone für Restorator/Optimum 4000 - SOS
56-1759 Standardpatrone für Restorator/Optimum 4000 - Lemon
56-1756 Standardpatrone für Restorator/Optimum 4000 - Summer Orange
56-1765 Patrone für Restorator/Optimum 4000 - Neutral mit 10% lemon
56-1369 Patrone für Restorator/Optimum 4000 - Berry
56-1370 Patrone für Restorator/Optimum 4000 - Früchte
56-1776 Patrone für Restorator/Optimum 4000 - Ocean
Verwenden Sie Vaportek überall und jederzeit! – Verwenden Sie Ihr Vaportek Gerät vor, während und nach jeder Schadensanierung!




UMWELTFREUNDLICH
KOMPAKTES, EFFIZIENTES UND VIELSEITIGES GERUCHSBESEITIGUNGSGERÄT – EINFACH ZU BEDIENEN.
DER RESTORATOR PRODUZIERT VAPORTEKS EINZIGARTIGEN AKTIVEN TROCKENDAMPF - DIE UMWELTFREUNDLICHE ALTERNATIVE ZUR OZONBEHANDLUNG
AUSGEWÄHLTE SPEZIFIKATIONEN
Der Restorator ist ein tragbares, elektrisches Gerät, das eine unschädliche Technologie verwendet, die schnell und effektiv Gerüche permanent entfernt und die Luft in Räumen erneuert. Der Restorator verwendet das von Vaportek patentierte Membransystem, das eine komplexe Mischung aus über 30 verschiedenen, und 100% rein natürlichen, ätherischen Ölen enthält, das heißt ausgepresste und in anderer Weise gewonnene Extrakte aus dem Pflanzenreich, wie z.B. Eukalyptus, Zedernholz, Pfefferminz, Kampfer, Kiefer, Lavendel, Zitrusfrüchte u.a.m. Wenn der eingebaute Ventilator des Restorator Luft über die Membran führt, öffnet sich die Membran und Öl wird als Trockendampf an die Luft freigegeben. Die Pflanzenölmoleküle des Trockendampfes sind extrem aktiv und breiten sich schnell im gesamten Bahandlungbereich aus und durchdringen effektiv poröse Oberflächen wie z.B. Holz, Beton, Tapeten, Gips, Ziegel, Dämmstoffe, Textilien usw. um schnell und effizient via molekularem Einkapseln und Geruchspaarung (siehe Seite 16-18) die Geruchsbelästigungen von Brand- und Rußschäden, Nikotin, Urin, Abwasser, Fäkalien, angebrannten Speisen, Schweiß, Erbrochenem, Schimmel, Verwesung, Tiere und andere Gerüche organischen Ursprungs zu beseitigen. Auch auf nicht porösen Oberflächen arbeitet der Trockendampf schnell und effektiv.
UMWELTGERECHTE TECHNOLOGIE
Die Vaportek Technologie basiert auf natürlichen Pflanzenextrakten und ist nicht gesundheitsgefährdend, und deshalb eine bessere Wahl als die Verwendung von Ozongeräten oder Trocken- und Feuchtnebelerzeugung. Im Gegensatz zur Ozonisierung, beschädigt der Restorator keine Textilien, Gummi, Kunststoffe, Klebemittel usw. Es wird keine Feuchtigkeit an den behandelten Raum abgegeben und deshalb wird das Risiko für Schäden eliminiert. Da die Methode für Menschen ungefährlich ist, müssen die Räume, die mit dem Restorator behandelt werden, nicht evakuiert werden. Die Räume sind während der Behandlung weiterhin nutzbar.
Dieses sehr vielseitige Geruchsbeseitigungsgerät ist für Bereiche geeignet, wo ein schnelles Ergebnis erforderlich ist, egal ob kleine Räume wie z.b. Autokabinen, Hotelzimmer oder ob größere Räume bis 600 m3 oder ca. 250 m2.
RESTORATOR BEHANDELT LUFT, HAUSRAT UND GEBÄUDE GLEICHZEITIG
RESTORATOR'S EINFACHES UND ROBUSTES DESIGN BEDEUTET VIELE JAHRE PROBLEMFREIER BETRIEB
OHNE WARTUNGKOSTEN UND MIT MINIMALEM STROMVERBRAUCH - "JUST PLUG AND PLAY"
• Behandelt Raumvolumen bis 566 m³ oder mehr, abhängig von Geruchsintensität und Geruchsart.
• Starke Konstruktion mit 2,2 mm vinylbekleidetem Stahlgehäuse und ABS-Verschlußkappen.
• Maß: 16 cm x 13 cm x 30 cm.
• Gewicht: 1,7 kg.
• Patronen werden in den Restorator eingesetzt und geben aktiven, geruchsneutralisierenden Trockendampf ab.
• Stromverbrauch: 11 Watt.
• Die Lebensdauer der Patronen beträgt ca. 200-300 Stunden.
RESTORATOR VERWENDUNGSZWECKE
• Geruchsbeseitigung nach Brand- und Wasserschäden usw.
• Geruchsbehandlung von Hotelzimmern und dergleichen.
• Autovermieter (Rauchgeruch usw. in Autos).
• Autohändler/Campinghändler.
• Krankenhäuser und Pflegeheime (Gesundheitswesen im Allgemeinen).
• Reinigungsunternehmen.
• Sporthallen.
• Immobilienmakler/Immobiliendienstleistungen.
• Generell in der Industrie und viele andere.

Tipp: Verwenden Sie ECOZ Geruchsbeseitigungskonzentrat in Ihrem Wasch-/Spülwasser beim Reinigen nach Brandschäden.
OZON- UND AEROSOLFREIE METHODE = MAXIMALE SICHERHEIT FÜR BENUTZER





DIE UMWELTFREUNDLICHE ALTERNATIVE FÜR OZON UND AEROSOLE ETC.
Optimum 4000 für permanente Installation gegen anhaltende Geruchs-/Luftprobleme.
Zugang zur Patrone
Auslaß des aktiven Trockendampfes, der den Geruch neutralisiert
Einstellung der Duft/Trockendampfintensität
An/Aus Schalter
Grüne Neon Kontrolleuchte
Gebrauchsanweisung auf der Unterseite



HINWEIS!
• Dieses System ist eine sichere und effektive Alternative zu Ozonisierung und Spray- und Aerosolverstäubung (Lufterfrischer).
• Keine Gesundheitsrisiken.
Art.-Nr. 56-1216
Wandhalterung mit Schloß für permanent Installation kann erworben werden

Vinylbekleidetes Stahlgehäuse

Optimum 4000 Patrone
Die Patrone ist in verschiedenen Duftvarianten erhältlich. Die Patronen halten ca. 3-5 Monate.
OPTIMUM 4000 Art.-Nr. 56-1216


PATRONEN SIND IN DEN FOLGENDEN AROMEN VERFÜGBAR:
56-1387 Standardpatrone für Restorator/Optimum 4000 - Neutrox Gamma
56-1769 Standardpatrone für Restorator/Optimum 4000 - SOS
56-1759 Standardpatrone für Restorator/Optimum 4000 - Lemon
56-1756 Standardpatrone für Restorator/Optimum 4000 - Summer Orange
56-1765 Patrone für Restorator/Optimum 4000 - Neutral m. 10% lemon
56-1369 Patrone für Restorator/Optimum 4000 - Berry
56-1370 Patrone für Restorator/Optimum 4000 - Früchte
56-1776 Patrone für Restorator/Optimum 4000 - Ocean
Verwenden Sie Vaportek überall und jederzeit! – Verwenden Sie Ihr Vaportek Gerät vor, während und nach jeder Schadensanierung!




DIE UMWELTFREUNDLICHE ALTERNATIVE FÜR OZON UND AEROSOLE ETC.
Optimum 4000 für permanente Installation gegen anhaltende Geruchs-/Luftprobleme.
FUNKTIONEN UND VORTEILE
Optimum 4000 ist das ursprüngliche Trockendampfsystem von Vaportek, das erstmals 1979 auf Krebsstationen und anderen medizinischen Einrichtungen verwendet wurde. Optimum 4000 ist hauptsächlich geeignet für Orte mit dauerhafter Geruchsbelästigung. Optimum 4000 gibt einen ungefährlichen Trockendampf ab, wenn das geruchsneutralisierende Pflanzenöl, das in der inneren Membran der Patrone versiegelt ist, über die Oberfläche der Membran mit Luft vorbeizieht. Entfernen Sie einfach die Abdeckung von der Patrone und setzen Sie die Patrone auf der Rückseite des Geräts ein und stellen Sie die gewünschte Trockendampfintensität ein. Der vom Optimum 4000 abgegebene Trockendampf wird schnell von Luftströmungen im gesamten zu behandelnden Bereich verteilt und beseitigt schnell und kortollierend üble Gerüche von Nikotin, Feuchtigkeit/Schimmel, Lebensmittel, biologischen Geruch, Schweiß, Fäkalien, Erbrochenem, Verwesung, Tiere und alle anderen Gerüche biologischen Ursprungs. Der aktive Trockendampf behandelt Luft, Gegenstände und Gebäude gleichzeitig.
PLATZIERUNG
Da der Trockendampf schwerer als Luft ist, empfehlen wir das Optimum 4000 Gerät so hoch wie möglich zu platzieren. Das Gerät sollte auf einer harten Oberfläche stehen und während des normalen Betriebs sichtbar sein. Optimum 4000‘s Vorder- und Rückseite darf nicht zugedeckt werden. Für den Einsatz in Bereichen mit grossem Sicherheitsbedarf kann Optimum 4000 in einer Wandhalterung mit Schloss montiert werden, so daß unbefugter Zugriff und Diebstahl des Geräts vermieden wird.
- Besser als ULV-Kaltvernebler – hinterlässt keine Feuchtigkeit, fast geräuschlos und behandelt größere Bereiche.
- Besser als Aerosole – sichere Formel und umweltfreundlichere Wirkstoffe.
- Besser als Ozongeräte – verwendet ungefährliche ätherische Öle, oxidiert nicht Materialien und erfordert keine Evakuierung von Behandlungsbereichen.
Die Regulierung der Stärke gewährleistet eine vollständige Kontrolle in Verbindung mit Gerüchen. Ein thermisch geschützter eingebauter Lüfter arbeitet leise und verwendet nur 16 W Strom. Die Patronen halten ca. 3-5 Monate.
NAC Europe
Ellegårdvej 18, DK-6400 Sønderborg
Tel +45 74 42 62 92
Info@nac-europe.com www.nac-europe.com
SPEZIFIKATIONEN
• Behandelt Räume bis zu 500-600 m3.
• Geräuschloser Betrieb.
• Stabile Konstruktion mit vinylbekleidetem Stahlgehäuse mit Kunststoffdeckeln an beiden Enden.
• Maß: H x B x L = 13 x 13 x 30 cm.
• Gewicht: 2 kg.
• Thermisch geschützter Motor mit 183 cm Erdungskabel.
• 5 Jahre Garantie.
• Hergestellt von Vaportek in den USA.
ANWENDUNGSBEREICHE:
• Untersuchungsräume
• Krankenhäuser
• Laboratorien
• Reinigungsservice
• Raucherbereiche
• Tierkliniken
• Zahnarztpraxis
• Lobbybereiche
• Institutionen
• Kapellen
• Seniorenheime
• Umkleidekabinen, Sport, Industrie
… und viele mehr

Tipp: Verwenden Sie ECOZ Geruchsbeseitigungskonzentrat in Ihrem Wasch-/Spülwasser beim Reinigen nach Brandschäden.
OZON- UND AEROSOLFREIE METHODE = MAXIMALE SICHERHEIT FÜR BENUTZER





Original Neutrox Gamma Bricks sind nicht ohne Grund zu einem "Must have" in der globalen Schadensanierung geworden. Dafür gibt es viele gute Gründe!
Das patentierte und einzigartige Geruchsneutralisationssystem von Vaportek setzt weltweit den Standard für umwelt- und anwenderfreundliche Geruchssanierung im Bereich Brand- und Wasserschadensanierung. Eine wissenschaftlich formulierte Zusammensetzung von über 30 verschiedenen Pflanzenextrakten bilden das Fundament in dem Vaportek Produktprogramm.
Das Öl wird Neutrox Gamma genannt und wurde ursprünglich für eine sichere und umweltfreundliche Neutralisation der Gerüche innerhalb des Gesundheitswesens und Pflegesektor entwickelt.
Neutrox Gamma Bricks geben einen unschädlichen Trockendampf auf Basis ätherischer Öle ab. Der Trockendampf besteht aus einer komplexen Zusammensetzung von über 30 verschiedenen 100% natürlichen Pflanzenextrakten. Der Trockendampf breitet sich schnell in der Luft aus. Er kapselt und neutralisiert auf molekularem Niveau unangenehme Gerüche nach Brand- und Rauchschäden, Wasserschäden, Abflußschäden, Proteinbrände, Chemikalien Leckage, Verwesung, Schimmel, Moder, Abfall, Speisedunst, Schweiß, Urin, Erbrochenem, Tiere u.a. ein.
ALLGEMEINE ANWENDUNG
Im Toilettenbereich, bei Müllcontainern, in Abfallräumen, Raucherzimmern, Belüftungskanälen und Müllschächten sowie unter Fußböden oder aufgehangen mit SCS (Simple Clip System) und in vielen anderen geruchsintensiven Bereichen. Die Neutrox Gamma Bricks können außerdem im Staubsauger und bei Geruchsneutralisation nach Schädlingsbekämpfung angewandt werden.
gamma oil
BESTSELLER

SCHADENSANIERUNG
SCHADENSANIERUNG
ZU BELIEBTEN ANWENDUNGEN
SEITE 40-45
Nach Brand- oder Wasserschäden werden ein oder mehrere Neutrox Gamma Bricks an geruchsintensiven Stellen angebracht. Neutrox Gamma Bricks können mit Erfolg in Entfeuchtungs-, Luftreinigungs- und Ventilationsgeräten verwendet werden, um Gerüche in Verbindung mit Wasser- und Brandschäden zu beseitigen. Die Bricks einfach dort anbringen, wo Luft vorbeipassiert und damit das aktive Neutrox Gamma Öl aufnehmen kann.
Art.-Nr. 56-1397 – Karton mit 4 x 30 Stck. in Plastikdosen.
Neutrox Gamma Bricks - Nur die Phantasie setzt Grenzen - Überall einsetzbar, wo schlechter Geruch ein Problem darstellt.

Wenn Sie Neutrox Gamma Bricks und ECOZ in Ihrem Servicewagen haben, können Sie 99% aller akuten Geruchsprobleme sofort lösen

Neutrox Gamma Bricks + ECOZ Ihr Erste-Hilfe-Kasten besteht aus







Original Neutrox Gamma Bricks sind nicht ohne Grund zu einem "Must have" in der globalenSchadensanierung geworden. Dafür gibt es viele gute Gründe!

Neutrox Gamma Bricks können mit Erfolg in Entfeuchtungs-, Luftreinigungs- und Ventilationsausrüstung verwendet werden, um Gerüche in Verbindung mit Wasser- und Brandschäden zu beseitigen. Bringen Sie Neutrox Gamma Bricks dort an, wo Luft vorbeiziehen kann und damit das Neutrox Gamma Öl aktiviert und Trockendampf freisetzt.

Kondensations-Entfeuchter
HEPA-Luftreiniger


AdsorptionsEntfeuchter

KLEINE GRÖSSE GROSSER EFFEKT NEU
Vaportek’s SOS Öl-Zusammensetzung ist wissenschaftlich entwickelt, um Gerüche nach Brandschäden zu neutralisieren. Platzieren Sie SOS Bricks in Ihren Luftent-feuchtern und Belüftungsgeräten und -Anlagen usw. für die volle Wirkung. Weitere Informationen zur SOS-Rezeptur finden Sie auf Seite 37.



BRICKS GIBT ES JEZTZ AUCH MIT SOS ÖL
DIE NEUE BELIEBTE ALTERNATIVE ZU DEN ORIGINAL NEUTROX GAMMA BRICKS
Enthält sensationelle Duftöle von hoher Qualität, die ein Lächeln verbreiten und Ihre Kunden begeistern werden.
Das patentierte und einzigartige Geruchsneutralisationssystem von Vaportek setzt weltweit den Standard für umwelt- und anwenderfreundliche Geruchssanierung im Bereich Brand- und Wasserschadensanierung.
Eine wissenschaftlich formulierte Zusammensetzung von über 30 verschiedenen Pflanzenextrakten bilden das Fundament in dem Vaportek Produktprogramm.
Vaportek Aroma Bricks ist eine Ergänzung zu den bekannten und bei den Schadensanierern sehr beliebten Neutrox Gamma Bricks.
Aroma Bricks sind in einer Reihe von exquisiten Düften erhältlich, die Ihnen gefallen werden und die einen positiven Beitrag zur Neutralisierung von Gerüchen leisten werden. Sie unterdrücken auch den imaginären Restgeruch, der in Verbindung mit verschiedenen Versicherungsschäden auftreten kann, wie Gerüche nach Brand, Kanal- und Schimmelschäden usw. Oder fügen Sie einfach einen von Ihnen ausgewählten Duft hinzu und machen Sie die Menschen glücklich!
Aroma Bricks von Vaportek bestehen ausschließlich aus hochwertig qualitativen, ätherischen Ölen und speziell ausgewählten Parfums. AromaBricks funktionieren genauso wie unsere beliebten Neutrox Gamma Bricks. Der kleine rechteckige Brick aus hochsaugfähiger Cellulosefaser ist mit der exquisiten Mischung aus feinen ätherischen Ölen und Duftstoffen gesättigt. Die Bricks wirken als Membran, d.h. wenn Luft über die Bricks geleitet wird, werden die Öle als winzige Duftmolekyle in die Luft freigesetzt und bereichern die Umgebung mit einem Duft, der von den Menschen in den Räumen als positiv wahrgenommenen wird.











AROMA BRICKS SIND IN DEN FOLGENDEN AROMAS VERFÜGBAR:
56-1707 Vaportek Summer Orange Bricks
56-1708 Vaportek Lemon Bricks
56-1750 Vaportek Cool Green Bricks
56-1730 Vaportek Berry Bricks (Beeren)

56-1948 Vaportek Ocean Bricks 56-1954 Vaportek Linen Bricks Karton mit 4 x 30 Stck. verpackt in Plastikdosen. (Kann nach Bedarf gemischt werden).



Aroma Bricks – Nur die Phantasie setzt Grenzen – Überall einsetzbar, wo schlechter Geruch ein Problem darstellt.
Vaportek Aroma Bricks ist eine sehr beliebte Ergänzung zu den beliebten und in der Schadensanierung viel angewandten Neutrox Gamma Bricks.
Aroma Bricks verbreiten hochwertigen Duft, der Ihre Kunden glücklich macht. Sie werden bei Ihren Kunden in positiver Erinnerung bleiben.






AROMA BRICKS - DIE NEUE BELIEBTE
Enthält sensationelle Duftöle von hoher Qualität, die ein Lächeln verbreiten und Ihre Kunden begeistern werden.
SCHADENSANIERUNG
Platzieren Sie einen oder mehrere Aroma Bricks in dem geruchsbelasteten Bereich, z.B. nach einem Brand, Abwasserschäden, Schimmelpilzbefall usw. Die Aroma Bricks können auch in Kondenstrocknern, Adsorptionstrocknern, Zentrifugal- oder Axi-allüftern oder anderen Luftgebläsen angebracht werden. Legen Sie
Aroma Bricks in Ihren Staubsauger oder direkt ins Lüftungssystem oder in andere Bereiche mit guter Belüftung. Verwenden Sie
Aroma Bricks in Trocknungsräumen für Hausrat sowie Kleidung, Möbel, technische Ausrüstung usw. oder in speziellen Geruchssanierungsräumen. Legen Sie beispielsweise Aroma Bricks in große Säcke mit schlecht riechendem Hausrat und dergleichen.
ANWENDUNGSBEREICHE:
• Im Toilettenbereich.
• In und um Abfallbehälter/in Abfallräumen.
• In Unterflurbehältern (Moloks) gelegt.
• In Lüftungskanälen.
• Mit Vaportek-Krokodilschnabel aufgehängt (SCS, Simple Clip-System).
• Nur die Phantasie setzt Grenzen! Neutrox Gamma, SOS und Aroma Bricks können überall verwendet werden und erzielen sofort gute Ergebnisse.
Probieren Sie die Energie erzeugenden und erfrischenden Aroma Bricks Lemon und Summer Orange

TIPPS & TRICKS ZU BELIEBTEN ANWENDUNGEN
SEITE 40-45

Ein Teil von Vaportek‘s "Fresh & Clean Citrus Concept"
Sowie Neutrox Gamma Bricks und SOS Bricks können auch Aroma Bricks erfolgreich in Entfeuchtungs-, Luftreinigungs- und Belüftungsausrüstung eingesetzt werden um Gerüche in Verbindung mit Wasser- und Brandschäden zu beseitigen. Bringen Sie Aroma Bricks dort an, wo Luft vorbeiziehen kann und damit die aktiven Öle aktiviert und Trockendampf freisetzt.
ERGEBNIS = SCHNELL, EINFACH, EFFIZIENT UND WIRTSCHAFTLICH




BESTSELLER SCHADENSANIERUNG
DIE QUALITÄT UND EFFIZIENZ DER SENSATIONIELLEN ECOZ DÜFTE SIND
UNSCHLAGBAR. UNSERE KUNDEN LIEBEN DAS ECOZ AROMA IN DER LUFT.
ECOZ GERUCHSNEUTRALISATOR-KONZENTRAT
ECOZ wurde speziell für den kommerziellen und institutionellen Einsatz zur Behandlung von Gerüchen auf Böden, Wänden und vielen anderen Oberflächen entwickelt. Beim Waschen von Kleidung und Textilien in Industriewaschmaschinen, wird ECOZ Linen dem letzten Spülgang hinzugefügt, um Rauch und andere üble Gerüche zu entfernen. Sichere und wirksame Produktrezepturen, mit natürlichen Inhaltsstoffen machen ECOZ-Konzentrate zur bevorzugten Wahl bei den professionellen Schadensanierungs- und Reinigungsunternehmen usw.
EIGENSCHAFTEN UND VORTEILE
Die wasserlöslichen Geruchsneutralisator-konzentrate von ECOZ verwenden eine innovative, pflanzenbasierte Technologie um die Anforderungen von Geruchskontrolle während der Bodenpflege sowie vielen anderen Reinigungsaufgaben zu erfüllen. Die Inhaltsstoffe basieren auf natürlichen ätherischen Ölen, die schlechten Geruch neutralisieren, anstatt nur chemisch zu maskieren oder synthetische Düfte anzuwenden. Dies ist einer der Gründe, warum die Vaportek-Technologie vom Fachpersonal in der Schadensanierung und in der Reinigungsbranche als sichere und effektive Methode zur Lösung von Qualitätsproblemen bezüglich Innenluft bevorzugt wird.
Nichttoxische geruchsneutralisierende ECOZ-Konzentrate wurden zur Verbesserung des Ergebnisses von Reinigungsarbeiten jeglicher Art entwickelt. ECOZ wird direkt dem Wasch- oder Spülwasser hinzugefügt. ECOZ ist 100% mit allen Reinigungsprodukten vereinbar und kann allen Arten von geruchsneutralen Seifen/ Reiniger zugesetzt werden. ECOZ ist ideell für das Spülwasser in Teppich- und Textilreinigungsmaschinen, sowie für alle Arten von Fußbodenpflege. ECOZ-Produkte enthalten 100% natürliche, duftende ätherische Öle und bauen auf natürliche Weise eine breite Palette von verschiedenen Gerüchen ab.
VERFÜGBAR IN 5 DÜFTEN
SIEHE BESCHREIBUNG JEDES ECOZ-AROMA KONZENTRATES AUF SEITE 46 UNTER TIPPS & TRICKS

EMPFOHLENE VERWENDUNGSZWECKE


Textil- und Teppichreinigungsmaschinen, Industriewaschmaschinen, Bodenreinigungsmaschinen, allgemeine Bodenwäsche, Urinalreinigung und Toiletten, Toilettenböden, Küchenböden, Mobil-Toiletten, Reinigung von Wänden, Decken usw. nach Ruß- und Brandschäden, Abfallbereiche und vieles mehr. ECOZ hinterlässt ein angenehmes, lang anhaltendes Aroma in der Luft.
EMPFOHLENE DOSIERUNG
Typisch ca. 20-100 ml pro. 10 Liter Wasch- oder Spülwasser abhängig von Geruchsart und Geruchsintensität.
HINWEIS
ECOZ-Produkte sind Konzentrate. Verwenden Sie daher immer das richtige Mischungsverhältnis und verwenden Sie das Produkt niemals konzentriert/unverdünnt.
ECOZ ist in den Aromen Classic Neutral, SOS, Lemon, Summer Orange und Linen erhältlich. ECOZ wurde speziell für die kommerzielle und institutionelle Anwendung zur Behandlung von Gerüchen auf Böden, Wänden und anderen wasserfesten Oberflächen entwickelt. ECOZ dient zur Kontrolle/Neutralisierung unangenehmer Gerüche bei Reinigungsarbeiten jeglicher Art. ECOZ ist 100% mit duftneutralen Reinigungskonzentraten vereinbar und kann ohne weiteres diesen Reinigungslösungen hinzugefügt werden. Die Duftstoffe von ECOZ (ätherische Öle) werden nicht bei hohen Temperaturen zersetzt. ECOZ schäumt nicht und hat einen neutralen pH-Wert. ECOZ kann auch mit Kaltverneblungsgerät, Pumpensprühern usw. auf Oberflächen angewendet werden. ECOZ kann auf porösen sowie nicht porösen Oberflächen beim Reinigen von Fußböden, Wänden, Teppichen, Textilien und Wäsche sowie als Raumerfrischer etc. verwendet werden.
Biologisch abbaubar. Ungiftig, nicht ätzend.





Enthält 100% ätherische Öle. Fleckt nicht, fettet nicht.
Entfernt eine Vielzahl von Gerüchen. Extrem vielseitige Anwendung.
Erhältlich in 1, 5, 20 und 208 Litern. Erhältlich in den Aromen: SOS (Smoke Odour Solution) Lemon, Summer Orange, Classic Neutral und Linen.
ALLE ECOZPRODUKTE JETZT OHNE FARBSTOFF
UMWELTFREUNDLICH





UNSCHLAGBAR. UNSERE KUNDEN LIEBEN DAS ECOZ AROMA IN DER LUFT.
ALLGEMEINE GEBRAUCHSANWEISUNG/DOSIERUNG
ECOZ kann im Verhältnis 1:5 bis 1:128 dosiert werden. 20-100 ml ECOZ pro 10 l Spül- und Waschwasser ist die Standarddosierung für diese effektive Geruchsneutralisator-konzentrat für die Schadensanierung. Höhere Dosierungen können verwendet werden, wenn ein stärkeres Aroma gewünscht wird oder wenn das Produkt als Raumerfrischer verwendet wird. ECOZ kann auch in Kaltverneblern, NAC Power Sprayers oder Pumpensprühern etc. eingesetzt werden. Wir empfehlen ECOZ Linen in Teppichund Textilreinigungsmaschinen/Waschmaschinen zu verwenden. Wenn ECOZ in Waschmaschinen verwendet wird, um Gerüche in Textilien zu entfernen, empfehlen wir 10-80 ml zum letzten Spülgang hinzu zufügen. Alle 5 Aromen können zum Waschen und zur Geruchsbehandlung von Hausrat und Inventar nach Brandschäden Schimmelschäden, Wasserschäden usw. verwendet werden.
ECOZ SOS (Smoke Odour Solution) ist speziell für die Geruchssanierung nach Brand- und Rauchschäden entwickelt. Sie erreichen eine optimale Neutralisierung von allen Arten von Rauchgeruch und vermeiden Geruchsverwirrung indem Sie das ECOZ SOS Geruchsneutralisator-konzentrat im Wasch- und Spülwasser zusammen mit dem Trockendampf der SOS Membranen oder Patronen in den effektiven Vaportek Geruchsbeseitigungssgeräten – Restorator und VaporShark – verwenden. Wir nennen dieses System synergistische Geruchskontrolle™. Verwenden Sie als Alternative zum SOS System auch ECOZ Classic Neutral zusammen mit dem Trockendampf des Neutrox Gamma Öls in Membranen oder Patronen. ECOZ Classic Neutral und das Neutrox Gamma Öl sind generell für alle Arten von Geruch geeignet. Die Produkte können zusammen aber auch separat benutzt werden, wenn die Geruchssanierung nicht von extremer Art ist. ECOZ Lemon und Summer Orange sind auch für den Einsatz im Wasch- und Spülwasser bei der Reinigung nach Bränden u.a.m. geeignet, da ECOZ Lemon und Summer Orange sich auch sehr gut mit dem Trockendampf von Neutrox Gamma und SOS Öl vertragen. ECOZ Lemon ist unser beliebtes ALLROUND Produkt.
BEI LEICHTEM RAUCHGERUCH Dosierung: in der Regel 20-50 ml pro 10 Liter Wasser hinzufügen. BEI MODERATEM RAUCHGERUCH Dosierung: 30-60 ml pro 10 Liter Wasser. IM FALLE VON SCHWEREM RAUCH Dosierung: 60-100 ml oder mehr pro 10 Liter Wasser. Wir verweisen auch auf das Produktetikett.
ALLE ECOZ-PRODUKTE JETZT OHNE FARBSTOFFE DER UMWELT ZU LIEBE
• Wirksames Produkt zum Abwaschen von Ruß bei Brandschäden.
• Textil-/Teppichreiniger.
• Zusatz zu Spül- und Reinigungswasser.
• Hotelzimmer.
• Reinigung von Toiletten/Urinalen.
• Mobil-Toiletten.
• Tierkliniken.
• Abfallbereiche.
• Badezimmerböden.
• in Waschmaschinen.
• Raucherzimmer und vieles mehr...

DUFTET EIN-





PACKUNGSGRÖSSEN UND ARTIKELNUMMERN:
1 LITER - 12 STCK. PRO KARTON
56-1524-1 Classic Neutral
56-1521-1 SOS
56-1526-1 Lemon
56-1527-1 Summer Orange
56-1525-1 Linen
5 LITER - 4 STCK. PRO KARTON 56-1524-5 Classic Neutral 56-1521-5 SOS.
56-1526-5 Lemon 56-1527-5 Summer Orange 56-1525-5 Linen
20 LITER - PRO STÜCK 56-1524-20 Classic Neutral 56-1521-20 SOS 56-1526-20 Lemon 56-1527-20 Summer Orange 56-1525-20 Linen
208 LITER - PRO STÜCK 56-1524-208 Classic Neutral 56-1521-208 SOS 56-1526-208 Lemon 56-1527-208 Summer Orange 56-1525-208 Linen
Hergestellt von Vaportek in den USA
SIEHE BESCHREIBUNG DER ECOZAROMA KONZENTRATE AUF SEITE 46 UNTER TIPPS & TRICKS

BIO-ENZYMATISCHE REINIGUNG UND GERUCHSENTFERNUNG
Spezialprodukt von Vaportek, bestehend aus einer komplexen Mischung von über 30 verschiedenen ätherischen Ölen (100% natürliche Pflanzenextrakte) und einer Suspension von Mikroorganismen und Enzymen.
BIO-C-FLÜSSIGKONZENTRAT FÜR DIE
ORGANISCHE GERUCHSNEUTRALISIERUNG
Bio-C enthält ätherische Öle, Enzyme und unschädliche Bakterienkulturen. Die einzigartige Vaportek Bio-C Produktlinie von wasserlöslichen Bio-C-Konzentraten baut auf der Stelle schnell, sicher und effektiv alle Gerüche organischen Ursprungs ab.
Bio-C verhindert das Verstopfen von Rohrleitungen und durchdringt Geruchsflecken und Verfärbungen organischen Ursprungs auf Fliesen und Fugen von Toiletten, Urinalen, Pissoirs, Baderäume, Badezimmern usw.
ANWENDUNG - SCHADENSSANIERUNG
Bio-C ist das perfekte Produkt zur biologischen Neutralisation und Abbau von Gerüchen durch Wasser- und Abwasserschäden, Feucht- und Schimmelschäden, Urin, Fäkalien, Körperflüssigkeiten im Zusammenhang mit Leichenfunden, Erbrochenem, Fäulnis, Tiere, Zigarettenrauch usw.
Die Formel von Bio-C ist einzigartig und besteht aus Millionen von unschädlichen Bakterienkulturen, Enzymen sowie Vaporteks Spezialmischung aus mehr als 30 ätherischen Ölen (100% natürliche Pflanzenextrakte).
Diese Eigenschaften machen Bio-C zur suveränen Wahl, wenn man Gerüche entfernen und kontrollieren möchte und gleich-
Zur Zersetzung und Neutralisierung von Gerüchen die bei Wasser- und Abwasserschäden entstehen, sowie Gerüche anderen biologischen Ursprungs.
ANDERE VERWENDUNGSZWECKE
• Behandlung von Abflüssen/Drän/Kloake.
• Toiletten/Urinale/Badezimmer/Umkleidekabinen usw.
• In und um Abfallbehälter, Behälter usw.
• Tropfsysteme.
• Abfallbeseitigungsanlage.
• Mobil-Toiletten.
BIO-C ENTFERNT BIOLOGISCHEN/ORGANISCHEN GERUCH


zeitig organischen Schmutz und Ablagerungen abbauen möchte.
BIO-C fördert und beschleunigt den natürlichen organischen Abbauprozess indem ein kraftvolles Gemisch von speziellen Bakterienkulturen sowie eine stabilisierte Komposition von Lipasen, Zellulasen, Proteasen und Amylasen Enzyme benutzt wird.
Bio-C kann in den meisten industriellen Umgebungen eingesetzt werden, wo Gerüche beseitigt werden sollen. Es ist besonders wirksam bei der Entfernung von Gerüchen von Fettabscheidern, Abfallbereiche, Abflüsse/Kläranlagen und septische Systeme.
ANWENDUNG
Sprühen Sie mit einem Handsprühgerät, Drucksprühgerät, NAC Power Sprayer oder speziellen Pumpen-/Düsensystemen direkt auf die Geruchsquelle.
Führen Sie Bio-C direkt in Abflüsse/Drän/Fettabscheider usw. z.B. mit unseren Dosierpumpen.
Wenden Sie sich an NAC Europe, um weitere Informationen zu Dosiersystemen zu erhalten.
BESEITIGUNG UND ABBAU DER GERÜCHE VON:
Urin/Fækalien, organischer Hausmüll, Krankenhausabfall, Rauch, Kanalisation, Fettabscheider, Fäulnis, Erbrochenem, Feuchtigkeit, Schimmel, Schweiß, Tiere, Blut, Milch, Öl und alle anderen Gerüche organischen Ursprungs.
BIO-ENZYMATISCHE REINIGUNG UND GERUCHSENTFERNUNG
• Geruchsbehandlung bei Schädlingsbekämpung z.B. Ratten.
• Katzenurin usw.
• Uringeruch durch Inkotinenz, Pflegeheime usw.
• Entfernung von Gerüchen in Teppichen und anderen Textilien.


Verwenden




BIO-ENZYMATISCHE REINIGUNG UND GERUCHSENTFERNUNG
Spezialprodukt von Vaportek, bestehend aus einer komplexen Mischung von über 30 verschiedenen ätherischen Ölen (100% natürliche Pflanzenextrakte) und einer Suspension von Mikroorganismen und Enzymen.
SPEZIFIKATION:
• Wassermischbares Konzentrat.
• Lagerungsstabilität etwa 12 Monate.
• Nicht brennbar und nicht ätzend.
• Funktioniert umgehend bei Kontakt und lange nach dem Auftragen.
• Mischverhältnis: Kann je nach Anwendung bis zu 1:150 mit Wasser verdünnt werden. Für den normalen Gebrauch mit z.B. einem Pumpzerstäuber wird eine Verdünnung von 1:5 bis 1:20 empfohlen.
• Multienzymatisch.
• Enthält unschädliche Bakterienkulturen.
• Enthält das einzigartige und unschädliche Vaportek Geruchsneutralisierungsadditiv (ätherische Öle).
• Verträgt keinen Frost.
• Biologisch abbaubar.
• Packungsgrössen:
1 Liter, 5 Liter, 20 Liter und 208 Liter.
BIO-C:
56-1523-1 Bio-C - 1 Liter
56-1523-5 Bio-C - 5 Liter
56-1523-20 Bio-C - 20 Liter
Beim Kontakt der Pflanzenextrakte mit dem Geruch, reagieren die Pflanzenmoleküle mit den Geruchsmolekülen indem sie diese einkapseln und neutralisieren. Der Prozess beginnt sofort. Es findet kein Maskieren des unangenehmen Geruchs statt, sondern eine echte Geruchsneutralisation.
2 Bio-C enthält eine entwickelte Suspension aus natürlichen Bakterienkulturen und Enzymen, die übelriechendes Material abbaut und die organische Stoffe in Wasser und Kohlendioxid umwandelt. Die Quelle des unangenehmen Geruchs wird somit dauerhaft beseitigt.

BIO-C ENTFERNT BIOLOGISCHEN/ORGANISCHEN GERUCH
ANWENDUNGSBEREICHE:
• Schadenssanierungsunternehmen
• Krankenhäuser und Pflegeheime
• Schulen und Sportzentren
• Wohnungsbaugesellschaften
• Schlachthöfe
• Kläranlagen
• Schädlinge
• Behandlungsanlagen

• Knochenmehlherstellung, fischverabeitende Industrie usw.
• Hotel- und Restaurantbranche usw.



BIOHAZARD

BIO-C JETZT OHNE FARBSTOFF UMWELTFREUNDLICH


TIPPS & TRICKS ZU BELIEBTEN ANWENDUNGEN
SEITE 50-51
SPEZIELL ENTWICKELT FÜR DIE ANWENDUNG IN GRÖSSEREN BELÜFTUNGS-, ENTFEUCHTUNGS- UND TROCKNUNGSANLAGEN UND VOR LUFTGEBLÄSEN ETC.
Verstellbarer Alu-Drehverschluß für Dosierung des Trockendampfes (an beiden Enden der Patrone)
Stativ, das die Patrone in der gewünschten Position hält
Stativ, der holder patronen i den ønskede stilling
GERUCHSKONTROLLE BEI GROSSEN SCHÄDEN
Legen Sie die HDS-Patrone in die Belüftungsanlage oder vor die Luftgebläse/ Ventilatoren als Sofortmaßnahme bei Geruchsbelästigungen/Geruchsbeschwerden nach z.B. Brand in Kaufhäusern, Einkaufszentren, Fabrikhallen usw.
Öffnung für den Luftstrom
Åbninger til luftgennemstrømning



neutrox gamma oil

Legen Sie die HDS-Patrone zur Geruchskontrolle in einen größeren Adsorptionstrockner.

HDS-PATRONEN GIBT ES IN FOLGENDEN AROMEN:
Art.-Nr. 56-1353 HDS-Patrone Neutrox Gamma standard
Art.-Nr. 90-2200-85 HDS-Patrone m. SOS Öl
Art.-Nr. 90-2200-86 HDS-Patrone m. Lemon
SPEZIFIKATIONEN
Verpackungsgröße: Karton mit 6 Stck.
Maße: 14,6 cm Höhe x 9,5 cm Durchmesser. Wirksam bis zu 8 Wochen bei normalem Gebrauch.
Behandelt Flächen bis 1800 m².
Der verstellbare Aluminiumdeckel sorgt für eine präzise
Dosierung des Trockendampfes.
Zubehör: Wiederverwendbares Patronenstativ, Nr. 90-2201.
OZON- UND AEROSOLFREIE METHODE = MAXIMUM SICHERHEIT FÜR DIE BENUTZER
Verwenden




SPEZIELL ENTWICKELT FÜR DIE ANWENDUNG IN GRÖSSEREN BELÜFTUNGS-, ENTFEUCHTUNGS- UND TROCKNUNGSANLAGEN UND VOR LUFTGEBLÄSEN ETC.
ANWENDUNGSBEREICHE
Die Vaportek HDS-Patrone wurde speziell für die Anwendung bei passiver Geruchskontrolle in Klima-/Lüftungsanlagen entwickelt. Sie wird sowohl in Hochleistungsentfeuchtern, Trocknungsanlagen und Luftreinigungsanlangen und dergleichen nach Wasser- und Brandschäden eingesetzt. Die Patrone enthält die hocheffiziente Vaportek-Membran, die einen unschädlichen, geruchsneutralisierenden Trockendampf freisetzt, der aus einer avancierten Mischung (unser Neutrox Gamma Öl) aus über 30 verschiedenen Pflanzenölen besteht. Vaportek hat diese Formel bei Geruchsbeseitigung in der Schadensanierung, Geruchskontrolle in Lebensmittelproduktion, Abfallbehandlung, im Gesundheitswesen, in Büros, Fabriken, Hotels und in Privathäusern auf der ganzen Welt seit mehr als 45 Jahren angewandt.
PLATZIERUNG
Die freistehende Patrone kann in jedes Lüftungssystem eingesetzt werden. Um den maximalen Effekt zu erhalten, platzieren Sie die Patrone in Längsrichtung und öffnen sie die verstellbaren Deckel an den Enden ganz oder teilweise, damit Luft durch die Patrone strömen kann. Die Patrone kann mit einem Ständer an Ort und Stelle gehalten werden. Wo die Luftströmungen sehr stark sind, kann die Patrone mit Klebeband oder doppelseitigem Klebeband befestigt werden. Die Patrone kann auch vor Luftgebläsen/Ventilatoren und dergleichen platziert werden um schnelle und effektive Geruchsbeseitigung, z.B. nach Brandschäden oder in Verbindung mit Teppichreinigung und dergleichen zu erreichen.
VORTEILE UND EIGENSCHAFTEN
Die Vaportek HDS-Patrone bietet eine sofortige und leistungsstarke Geruchskontrolle in Bereichen in denen die meisten anderen Systeme nicht ausreichen. Der geruchskontrollierende Trockendampf durchdringt schnell die porösen Oberflächen mit denen er in Kontakt kommt.


AKUTE GERUCHSKONTROLLE
Der Ständer dient dazu die Patrone im gewünschten Zustand zu halten. Drehen Sie die einstellbaren Alu-Drehverschlüße der Patrone in die gewünschte Position und setzen sie die Patrone horizontal in den Ständer. Setzen Sie die Patrone in einen Luftkanal oder vor eine Luftklappe, wo die Luft durch die Patrone fließen kann.

GLEICHZEITIGE GERUCHSENTFERNUNG UND TROCKNUNG BEI BRAND- UND WASSERSCHÄDEN
Platzieren Sie die Heavy-Duty Standalone-Patrone in einem Ständer, an den Sie ein Luftgebläse/einen Ventilator anschließen. Dabei wird sowohl aktiver Trockendampf zur Geruchsentfernung, als auch Luft zum Trocknen nach Wasser- und Brandschäden freigestezt.



Tipp: Verwenden Sie bei der Reinigung von Brandschäden die ECOZ-Konzentrate in Ihrem Wasch-/Spülwasser.



UMWELTFREUNDLICHE GERUCHSNEUTRALISATION MIT REINER "PFLANZENENERGIE"
Seit dem Start von Vaportek im Jahr 1979 ist das einzigartige Neutrox Gamma Öl das Fundament des globalen Erfolgs des Unternehmens und die wissenschaftlich komplexe Mischung natürlicher Öle wurde noch nicht kopiert, einfach weil es nicht möglich ist!
Die Vaportek Technologie ist eine einzigartige Methode zur sicheren, effektiven und einfachen Geruchsneutralisierung. Die Methode hat weltweit neue Standards innerhalb der Schadensanierungsbranche für eine umwelt- und nutzerfreundliche Geruchssanierung gesetzt.
Eine wissenschaftlich formulierte und patentierte Zusammensetzung von über 30 verschiedenen und 100% natürlichen aromatischen Pflanzenextrakten bilden das Fundament im vielseitigen Produktprogramm von Vaportek. Diese komplexe Mischung von ätherischen Ölen nennt sich Neutrox Gamma. Sie wurde Ende der 70‘er Jahre von einem angesehenen amerikanischen Arzneimittelhersteller für eine sichere und effektive Neutralisierung von Gerüchen innerhalb des amerikanischen Gesundheitswesens entwickelt. Heute wird Vaportek mit großem Erfolg in vielen verschiedenen Branchen und Industriezweigen benutzt.
Das Neutrox Gamma Öl ist hermetisch in einer speziellen Kunststoff-Membrane versiegelt. Wenn der eingebaute Ventilator der Vaportek Geräte Luft über die Membran führt, öffnet sich die Membran, und Öl wird als Trockendampf an die Luft freigegeben. Der Trockendampf ist in der Luft extrem aktiv und die mikroskopischen Pflanzenöl Molekyle durchdringen schnell poröse Oberflächen wie z.B. Textilien, Tapete, Beton, Ziegelsteine, Holz, Gips und andere Baumaterialien um dann auf molekylarem Niveau, Gerüche von Rauch- und Rußschäden, Schimmel, Abwasser,



angebrannten Speisen, Verwesung, Abfall, Urin, Erbrochenem, Schweiss, Tieren und anderen Geruch organischen Ursprungs zu neutralisieren und zu entfernen.
DIESER NEUTRALISIERUNGSPROZESS NENNT SICH "ZWAARDEMAKER PAIRS"
Intensive Forschung einzigartiger ätherischer Öle, die auch in der Arzneimittelherstellung eingesetzt werden, hat gezeigt, daß viele dieser Öle die Fähigkeit haben, Gerüche zu neutralisieren, wenn ein ätherisches Öl mit einem bestimmten Geruchsmolekyl gepaart/kombiniert wird.
Die Zusammensetzung von Vaporteks orginal Neutrox Gamma Öl und SOS Öl basiert auf dieser wissenschaftlichen Erkenntnis, daß ätherische Öle Gerüche neutralisieren. NEUTROX GAMMA IST IN FOLGENDEN
Weitere Informationen wie ätherische Öle den Geruch nach der Zwaardemaker Pairs Methode neutralisieren finden Sie auf den Seiten 16-18.
Zusammen mit dem Neutrox Gamma Öl in Membranen/ Patronen empfehlen wir die Verwendung von ECOZ wasserlöslichen Geruchsneutralisationskonzentrate Classic Neutral, Lemon oder Summer Orange.


- Classic Neutral
56-1352 Neutrox Gamma Membran für VaporShark
56-1387 Neutrox Gamma Restorator Patrone für Restorator
56-1353 Neutrox Gamma HDS-Patrone

UMWELTFREUNDLICH!




UMWELTFREUNDLICH
UMWELTFREUNDLICHE GERUCHSNEUTRALISATION MIT REINER "PFLANZENENERGIE"
Vaportek - Unbegrenzte Möglichkeiten - Entfernt alle Arten von Gerüchen!
Das SOS Öl ist wissenschaftlich formuliert und speziell für die Geruchssanierung nach Brand- und Rauchschäden entwickelt. Vaportek bietet jetzt dieses Öl als Alternative zum originalen und populären Neutrox Gamma Öl an. Der SOS Duft ist sehr angenehm – aber dennoch kraftvoll und effektiv. Diese Eigenschaften machen das Öl ideell für die Neutralisierung von Rauchgeruch in Privatgebäuden und in anderen Bereichen, wo Menschen sich aufhalten. Gleichzeitig wird das Arbeitsklima für die Mitarbeiter der Schadenservicebranche verbessert. SOS ersetzt nicht das Neutrox Gamma Öl, sondern soll als eine neue und innovative Alternative bei allen Arten von Rauch- und Rußschäden betrachtet werden. Das SOS Öl gibt es als Industriemembran für den VaporShark, sowie als Patrone für den Restorator, SOS Bricks und als HD Stand-Alone Patrone für Geruchsbeseitigung in Belüftungskanälen.
Weitere Informationen wie ätherische Öle den Geruch nach der Zwaardemaker Pairs Methode neutralisieren finden Sie auf den Seiten 16-18.
Zusammen mit dem SOS Öl in Membranen/ Patronen empfehlen wir die Verwendung von ECOZ wasserlöslichen Geruchsneutralisationskonzentrate SOS, Classic Neutral, Lemon oder Summer Orange.



SOS IST IN FOLGENDEN PRODUKTEN VERFÜGBAR:

56-1521-1 ECOZ Geruchsneutralisationskonzentrat SOS 56-1766 SOS-Membran für VaporShark 56-1769 SOS-Restoratorpatrone für Restorator 90-2200-85 SOS HDS-Patrone 56-1709 SOS Bricks
IDEAL FÜR:
Proteinbrände
Angebrannte Speisen, verbranntes und verkohltes Fleisch und die meisten Brände, wo lebendes Zellengewebe und Haarproteine involviert sind.
Holz-/Papierbrände
Brände in Dachgeschösser usw. Schornsteinbrände, Explosionsbrände und Brände in Gebäuden und generell dort, wo Holzkonstruktionen involviert sind.
Synthetische Brände
Teppiche und Polstermöbel, Brände in elektrischen Anlagen und generell dort, wo Kunststoffe verbrennen.
Zigarettenrauch
Privatgebäude, Wohnungen, Restaurants, Wartesäle, Fahrzeuge und überall dort, wo Tabakrauch ein Problem darstellt.
"Wir verwenden SOS Öl mit großem Erfolg bei allen Arten von Bränden. Die Kunden sind sehr zufrieden, und jeder schätzt das milde Aroma, was das SOS Öl freisetzt."
Allan Nielsen, Abteilungsleiter Polygon A/S, Struer - Dänemark

BRICKS GIBT ES JEZTZ AUCH MIT SOS ÖL

Mit Vaporteks Fresh & Clean Citrus Concept preisen wir die fantastischen Fähigkeiten der Produkte an, weil sie funktionieren und die Menschen happy machen. Zitrusdüfte sind mit Reinheit und Frische verbunden. Besonders unter den Schadenssanierern ist der Duft von Reinheit und Frische beliebt! Fresh & Clean Citrus Concept ist ein sicherer Erfolg!
Seit dem Start von Vaportek im Jahr 1979 ist das einzigartige Neutrox Gamma Öl das Fundament des globalen Erfolgs des Unternehmens und die wissenschaftlich komplexe Mischung natürlicher Öle wurde noch nicht kopiert oder nachgeahmt, einfach weil es nicht möglich ist! Zusammen mit dem gleichfalls wissenschaftlich formulierten SOS Öl (Smoke Odour Solution) sind diese zwei Öle die beliebt unter den Schadensanierern und schaffen überzeugende Ergebnisse, wenn es um die Beseitigung von hartnäckigen Gerüchen nach einem Brand und anderen übelriechenden Schäden geht.
Als eine frische und wohlduftende Initiative stellt Vaportek das Fresh & Clean Citrus Concept mit den allseits beliebten Zitrusdüften vor. Fresh & Clean Citrus Concept ist in einer Lemon Version und in einer Summer Orange Version erhältlich.
Der beliebte Vaportek Lemonduft war schon immer einer unserer Bestseller. Lemon und Summer Orange Versionen sind als Membranen für VaporShark, Patronen für Restorator, sowie Aroma Bricks und die ECOZ Geruchsbehandlungskonzentrate erhältlich.
ANWENDUNG VON LEMON MEMBRANEN UND PATRONEN IN VAPORSHARK UND RESTORATOR
ECOZ Lemon ist seit mehreren Jahren einer unserer Bestseller unter den ECOZ-Produkten, auch als Membranen und Aroma Bricks, weil Vaportek's Lemon Produkte fantastisch duften! Der Grund für das frische, saubere und wirksame Zitrusaroma ist die Verwendung von echten ätherischen Ölen aus verschiedenen Zitrusfrüchten. ECOZ Le-
mon wird in der Fachsprache als Kopfnotenduft bezeichnet. Kopfnotendüfte sind frisch und basieren auf Zitrusfrüchten wie Zitrone, Bergamotte, Orange, Mandarine, Grapefruit usw.
Lemon membranen und -patronen werden für leichtere Gerüche separat verwendet, wo sie die behandelten Räume mit einem natürlichen, frischen und faszinierenden köstlichen, sauberen Zitrusduft erfüllen. Lemon membranen können auch in Kombination mit SOS oder Neutrox Gamma Membranen angewandt werden, bei schweren Geruchsschäden, bei denen die primäre Geruchsneutralisation von Neutrox Gamma oder SOS Öl herstammt, aber mit Lemon einen Hauch von belebendem, frischem und wunderbarem Zitrusduft geben, den Ihr Kunde zu schätzen weiß. Zitrusmembranen wirken auch antiseptisch.
NEU! SUMMER ORANGE – ANWENDUNG VON SUMMER ORANGE MEMBRANEN UND PATRONEN IM VAPORSHARK UND RESTORATOR Das neueste Produkt von Vaportek ist ein frischer und wohlriechender Kopfnotenduft: Summer Orange. Vaportek hat den Duft von frisch gepressten Apfelsinen erfolgreich eingefangen. Summer Orange Membranen und Patronen sind frisch, sprudelnd und warm und der Duft setzt sich aus Mandarine , Orange, Blutorange, Grapefruit usw. zusammen. Weder Lemon noch Summer Orange membranen ersetzen die Verwendung von Neutrox Gamma oder SOS Membranen, weil diese auf einer wissenschaftlichen Formel beruhen, die Gerüche neutralisieren. Lemon und Summer Orange membranen können nach der Behandlung mit Neutrox Gamma oder SOS verwendet werden, um dem Raum einen frischen Touch zu geben.
Es ist wissenschaftlich erwiesen, daß
ätherische Öle aus Zitrusfrüchten
die Menschen glücklich machen!
Unsere Kunden lieben die Vaportek-Zitrusprodukte Lemon und Summer Orange, die als Membranen, Aroma Bricks und ECOZ Konzentrate erhältlich sind. Diese können je nach Bedarf einzeln oder in Wechselwirkung miteinander verwendet werden. Über einige der am häufigsten verwendeten Zitrusöle in den oben genannten Produkten heißt es:

GRAPEFRUIT: Verleiht neue Energie und gute Laune - schärft die Konzentration
ZITRONE: Gibt gute Laune und Energie - hilft Ihnen, sich zu konzentrieren
BERGAMOT: Gibt neue Energie und wirkt erfrischend
ORANGE: Gibt gute Laune und wirkt erfrischend
MANDARIN: Gibt Energie und gute Laune
Ergebnis: Ihre Kunden werden sich freuen, wenn sie die frische Brise von Lemon oder Summer Orange spüren





UMWELTFREUNDLICHE KONTROLLE MIT REINER "PFLANZENENERGIE"
Vaportek - Unbegrenzte Möglichkeiten - Entfernt alle Arten von Gerüchen!
MEMBRANEN FÜR VAPORSHARK:
- SOS (Smoke Odour Solution)
- Neutrox Gamma
- Summer Orange
- Lemon
- Siehe auch Seite 21

PATRONEN FÜR RESTORATOR:
- SOS (Smoke Odour Solution)
- Neutrox Gamma
- Lemon
- Summer Orange
- Andere Düfte auf Seite 22






HOLEN SIE DAS BESTE AUS IHREM VAPORSHARK
Verwenden Sie Neutrox Gamma oder SOS allein oder in Kombination mit Lemon oder Summer Orange Membran.




BESTSELLER PRODUKTE DES FRESH & CLEAN CITRUS KONZEPTES
Lemon & Summer Orange als ECOZ Konzentrat und Aroma Bricks, basierend auf echten ätherischen Ölen für wirksame und duftende Ergebnisse, die Ihre Kunden lieben werden!

& spritziger Orangenduft
HOLEN SIE DAS BESTE AUS IHREM RESTORATOR
Verwenden Sie Neutrox Gamma, SOS, Lemon oder Summer Orange Patronen aus unserem Fresh & Clean Citrus Concept.


Zitrusduft


Info@nac-europe.com
HOLEN SIE DAS BESTE AUS IHREN VAPORTEK-PRODUKTEN UND GEWINNEN SIE ZUFRIEDENE KUNDEN
VAPORTEK NEUTROX GAMMA BRICKS
Neutrox Gamma Bricks sind einer unserer Bestseller bei den europäischen Schadensanierungsunternehmen.
ANWENDUNG BEI BRANDSCHÄDEN
Alle Arten von Bränden – verbranntes synthetisches Material, Proteinbrände, verbranntes Holz und andere Baumaterialien.
Neutrox Gamma Bricks können überall nach einem Brand platziert werden. Platzieren Sie Neutrox Gamma Bricks auf speziell exponierten Stellen mit Geruchsbelästigungen. Je größer der Luftstrom ist, um so besser können die ätherischen Pflanzenöle als aktiver geruchsneutralisierender Trockendampf freisetzt werden. Platzieren Sie daher Neutrox Gamma Bricks auch an Orten mit Durchzug oder guter Belüftung, oder auch direkt in Lüftungskanälen.
Bei Geruchsproblemen in größeren Räumen können Sie ein Zenrifugal-, Axial- oder anderes Luftgebläse im Raum aufstellen, und ein oder mehrere Neutrox Gamma Bricks am Lufteinlaß og Auslaß anbringen, oder dort wo der Luftstrom des Lüfters ist oder gegebenenfalls direkt in den Luftschlauch. Der aktive Neutrox GammaTrockendampf wird freigesetzt und der unangenehme Geruch von Ruß/Rauch wird unterdrückt/neutralisiert. Sie können auch einen Neutrox Gamma Brick an unseres S.C.S. anbringen (Simple Clip System) und dann die S.C.S.-Kette an Ihrem Luftgebläse aufhängen. Siehe Bild Seite 14.
Bei anschließender Entfeuchtung von Löschwasser kann Neutrox Gamma Bricks im Kondenstrockner, Adsorptionstrockner oder Luftgebläse/Lüftungsgeräte usw. montiert werden für weiterhin dauerhafte Geruchsbehandlung.
ANWENDUNG BEI WASSER- UND ABWASSERSCHÄDEN
Alle Arten von Feuchtigkeits- und Wasserschäden, bei denen Geruch ein Problem darstellt. Abwasser, Prozesswasser, biologisch kontaminiertes Wasser usw.
Neutrox Gamma wird dort platziert, wo Geruch nach einem Wasserschaden ein Problem ist. Sprühen Sie eventuell zuerst die kontaminierten Oberflächen mit Vaportek Bio-C ein, welches den organischen Geruch mit ätherischen Ölen, Enzymen und Mikroorganismen zersetzt. Platzieren Sie auch Neutrox Gamma Bricks in Vaportek S.C.S. (Simple Clip System) und befestigen Sie es an Ihrem Lüftungsgerät, Zentrifugal- oder Axialgebläse.
Während des Entfeuchtungsprozesses können Neutrox Gamma Bricks in Kondens- oder Adsorptionstrocknern oder Luftgebläsen zur weiteren und dauerhaften Geruchsbehandlung installiert werden.
SCHADENSANIERUNG
BRICKS GIBT ES JEZTZ AUCH MIT


ANWENDUNG BEI FÄKALIEN, ERBROCHENEM, URIN, VERFAULTEM FLEISCH UND ANDEREN BIOLOGISCHEN GERÜCHEN
Besprühen Sie zuerst alle Oberflächen mit Vaportek Bio-C, das die organisch-biologische Kontamination abbaut und verwenden Sie danach Neutrox Gamma Bricks in Ihren Lüftungsgeräten und dergleichen.
ENTFERNUNG EINES IMAGINÄREN RESTGERUCHES
In Fällen, in denen ein imaginärer Restgeruch wahrgenommen wird, kann man mit Hilfe von Neutrox Gamma oder Aroma Bricks Abhilfe schaffen. Ein imaginärer Restgeruch ist der Geruch, der nur vom Kunden wahrgenommen wird, aber eigentlich nicht vorhanden ist. Mit Neutrox Gamma Bricks oder Aroma Bricks kann das Problem gelöst werden.
Sie werden feststellen, daß Neutrox Gamma Bricks ein super Produkt zur akuten Beseitigung von Gerüchen in Situationen, in denen es schnell gehen muss, ist. Das Ergebnis werden zufriedene Kunden sein, denn sie merken schnell und schätzen es, daß Sie etwas getan haben um den unangenehmen Geruch zu entfernen.
NEUTROX GAMMA BRICKS ENTFERNEN/NEUTRALISIEREN ALLE ARTEN VON GERÜCHEN!
Neutrox Gamma Bricks enthält aktives Neutrox Gamma Öl, das eine Vielzahl unterschiedlicher Gerüche, die durch Brand- und Rußschäden, Schimmel, Abwasser, übelriechendes industrielles Abwasser, Verfall einschließlich Leichengeruch, organischer Hausmüll einschließlich Sickerwasser, Erbrochenem, Urin, Schweiß, Schädlinge entstanden sind, entfernt/neutralisiert.




HOLEN SIE DAS BESTE AUS IHREN VAPORTEK-PRODUKTEN UND GEWINNEN SIE ZUFRIEDENE KUNDEN
NEUTROX GAMMA BRICKS KÖNNEN ÜBERALL ANGEWENDT WERDEN!
Legen Sie die Neutrox Gamma Bricks in die mitgelieferten Aluminiumschalen und platzieren sie die Schalen in Häusern und Gebäuden, um Gerüche sofort zu kontrollieren. Legen Sie Neutrox Gamma Bricks in Kondens- und Adsorptionstrockner, Belüftungsanlagen, Radial- und Axialgebläse, HEPA Luftreiniger sowie in alle andere technische Geräte, die einen Luftstrom erzeugen.
Legen Sie Neutrox Gamma Bricks in Lüftungskanäle. Platzieren Sie Neutrox Gamma Bricks an schwer zugänglichen Stellen, wie unter
Böden, Kriechkeller, Dachböden, Zwischengeschosse, Hohlräume usw. Die Anzahl der Neutrox Gamma Bricks, die Sie anwenden müssen bei den individuellen Aufgaben, ist abhängig von Geruchsart, Geruchsintensität und Volumen des Raumes.
Es gibt keine Grenzen, wo Sie dieses kleine, aber äußerst effektive Produkt, das Ihnen mit aktivem Trockendampf aus Vaportek Neutrox Gamma Öl die volle Leistung verleiht, verwenden können.

Wenn Sie die Luft mit einem milden und wunderbaren Duft bereichern möchten, können Aroma Bricks genauso verwendet werden, wie Neutrox Gamma Bricks!






Neutrox Gamma Bricks werden erfolgreich in Entfeuchtungs- und Luftreinigungsgeräten, samt diversen Gebläsen und Belüftungsanlagen zur Geruchskontrolle im Zusammenhang mit der Sanierung nach Wasserund Brandschäden usw. verwendet. Luft zieht an den Bricks vorbei und aktives Neutrox Gamma Öl wird freigesetzt, welches in geruchsneutralisierender Trockendampf umgewandelt wird.
Geruchskontrolle, z.B. im Zusammenhang mit der Entfeuchtung von allgemeinen Feuchtigkeits- und Wasserschäden sowie Wasserschäden verursacht durch Löschwasser.




Platzieren Sie Neutrox Gamma, SOS oder Aroma Bricks im Lufteinlaß oder Luftauslaß




Kann auch in Schläuche gelegt werden








HOLEN SIE DAS BESTE AUS IHREN VAPORTEK-PRODUKTEN UND GEWINNEN SIE ZUFRIEDENE KUNDEN
2 WÄRMETROCKNUNG VON WASSERSCHÄDEN MIT DRYMATIC WÄRMETROCKNUNGSAUSRÜSTUNG








Legen Sie die Neutrox Gamma, SOS oder Aroma Bricks in den Lufteinlaßschlauch der Drymatic II ein (Bild 1) oder setzen Sie sie in Boden - oder Wandmatten zusammen mit dem Boost Bar (Bild 2).
3 ZENTRIFUGALLÜFTER
Geruchskontrolle nach z.B. Brand- und Wasserschäden.


Klemmen Sie Neutrox Gamma, SOS oder Aroma Bricks in Vaportek S.C.S (Simple Clip System) und montieren Sie es am Luftgebläse beim Luftein- oder Luftauslaß.
4 BODENVENTILATOR
Geruchskontrolle nach z.B. Brand- und Wasserschäden.


Verwenden
Klemmen Sie Neutrox Gamma, SOS oder Aroma Bricks in Vaportek S.C.S (Simple Clip System) und montieren Sie sie an der Vorder- oder Rückseite des Bodenventilators.









HOLEN SIE DAS BESTE AUS IHREN VAPORTEK-PRODUKTEN UND GEWINNEN SIE ZUFRIEDENE KUNDEN
Geruchskontrolle nach z.B. Brand- und Wasserschäden.






Klemmen Sie Neutrox-Gamma, SOS oder Aroma Bricks in Vaportek S.C.S. (Simple Clip System) und montieren Sie sie am Lufteinlaß oder -auslaß des Luftgebläses. Legen Sie auch Neutrox Gamma, SOS oder Aroma Bricks in die Luftschläuche.
Vorschlag für andere Anwendungsbereiche:



Lemon oder Summer Orange Aroma Bricks in Ihrem Servicewagen platziert, werden vom Kunden positiv wahr genommen.
"Kleine Dinge machen den Unterschied". Der Geruchssinn ist direkt mit dem Bereich des Gehirns verbunden (das limbische System), das Gedächtnis, Emotionen und Instinkte steuert. Riecht es sauber und frisch, wenn Sie Ihre Aufgabe beendet haben, nimmt der Kunde das als positiv wahr – Das bedeutet positives Branding Ihres Unternehmens, Verbesserung des professionellen Images und Stärkung Ihrer Wettbewerbsfähigkeit.

Verwenden Sie
Neutrox Gamma Bricks zur Geruchsentfernung nach Schädlingen – ggf. zuerst den Bereich mit Bio-C besprühen.

Verwenden Sie
Neutrox Gamma- oder Aroma Bricks bei Haustiergerüchen, wie z.B. Urin, nasser Hund, Fäkalien usw. Bei Bedarf sprühen Sie zuerst mit Bio-C.


Verwenden Sie
Neutrox Gamma oder Aroma Bricks Lemon oder Summer Orange bei Entfeuchtung. Es hinterlässt einen frischen Duft, den Ihre Kunden lieben werden.

Brand in der Wohnung bedeutet oft Geruch, der die Menschen stört. Platzieren Sie
Neutrox Gamma Bricks in Treppenhäusern und die Nachbarn werden keine Geruchsbeschwerden haben.
So bekommen Sie zufriedene Kunden! Schenken Sie den Kunden einen Aroma Brick in einer EZ-Twist. Der Kunde wird sich auch nach dem Schaden noch an Ihre Firma erinnern.
HOLEN SIE DAS BESTE AUS IHREN VAPORTEK-PRODUKTEN UND GEWINNEN SIE ZUFRIEDENE KUNDEN
Geruchskontrolle bei z.B. Schimmelsanierung und Wasserschaden.


Platzieren Sie ein Neutrox Gamma Brick, SOS oder Aroma Brick im Luftein- oder Auslaß.








8 BELÜFTUNGSKANÄLE
Geruchskontrolle bei Geruch in Belüftungskanälen und/oder Geruch in Räumen, die durch Belüftungskanäle belüftet werden.
Platzieren Sie einen oder mehrere Neutrox Gamma Bricks oder eine Heavy-Duty Standalone-Patrone (HDS) im Lüftungskanal. Hiermit entfernen/kontrollieren Sie Gerüche, die vom Lüftungskanal stammen und behandeln damit gleichzeitig auch Räume/Räumlichkeiten, die mit Luft aus demselben Lüftungskanal versorgt werden. Im Lüftungskanal wird aktiver Trockendampf in mehrere Räume verteilt und damit wird die Geruchsbelästigung eliminiert.
















HOLEN SIE DAS BESTE AUS IHREN VAPORTEK-PRODUKTEN UND GEWINNEN SIE ZUFRIEDENE KUNDEN
Professionelle støvsugere
9
FRISCHER GERUCHSNEUTRALISIERENDER DUFT BEIM STAUBSAUGEN
En kendt og respekteret arbejdshest - effektiv og driftssikker til rengøring af store arealer
Geruchskontrolle beim Staubsaugen.
Nilfisk VP930 er den pålidelige partner til krævende rengøringsopgaver på
hoteller, skoler, kontorer og hospitaler. Robust og stabil med stor
støvsugerpose, der rummer 15 liter.
Det gennemtænkte design optimerer luftstrømmene og reducerer energitabet til et absolut minimum, samtidig med at det gør VP930 til en af de mest lydsvage professionelle støvsugere i verden.
Das Staubsaugen in der Schadensanierung kann zu Unannehmlichkeiten führen wegen schlechten Geruches vom Staubsauger. Fügen Sie ein oder mehrere Neutrox Gammaoder Aroma Bricks in den Staubsaugerbeutel, daneben oder in Verbindung mit dem HEPA-Filter.
Resultatet er fremragende sugestyrke og imponerende holdbarhed. Det er grunden til, at vores kunder holder sig til VP930 år efter år.
• Meget lavt støjniveau


Enestående holdbarhed med robust stålbeholder
Kvalitetskomponenter
Stor kapacitet med 15 liter støvpose
HEPA H13-filter som standard
Neutrox Gamma Bricks oder Aroma Bricks verwandeln jeden schlechten Geruch zu einem angenehmen Duft um, der positiv von Ihrer Umgebung wahrgenommen wird.
Parkeringsløsning som standard 2 hastigheder på flere modeller
GERUCHSKONTROLLE IN AUTO UND BOOT USW.
● Standardudstyr Standardtilbehør
Effektive Geruchsbeseitigung – Beugt schlechten Geruch in Autos, Autocamper, Boote, Wohnwagen, Ferienhaus usw. vor.
Slanger og koblinger Slanger og og koblinger og






alu 500 mm 1 stk. Ø32


Legen Sie Neutrox Gamma oder Aroma Bricks in die mitgelieferte Aluminiumschalen in Schränke, unter Autositze usw. oder teilen Sie einen Brick in der Mitte und legen Sie es in eine EZ-Twist – Montieren Sie die EZ-Twist mit dem Klettverschluss.
Kombinieren Sie einen Neutrox Gamma Brick mit beispielsweise Lemon oder Summer Orange Aroma Brick. Das gibt eine effektive Wirkung von Neutrox Gamma Bricks mit einem frischen Hauch von 100% natürlichem Zitrusduft. Ihre Kunden werden es lieben!













SEITE 30-31
BESCHREIBUNG VON ECOZ GERUCHSNEUTRALISATOR-KONZENTRAT.
ERZIELE DAS BESTE AUS DEN VAPORTEK-PRODUKTEN UND GEWINNE ZUFRIEDENE KUNDEN
UNIVERSAL ANWENDBAR FÜR GERUCHSBESEITIGUNG UND LUFTERFRISCHUNG
Ätherische Öle von Zitrusfrüchten. Zitrone, Bergamotte, Grapefruit, Limette usw. Guter natürlicher Duft von frischen Zitrusfrüchten. ECOZ Lemon-Version ist einer der absoluten Favoriten unserer Kunden und gehört zum neuen "Fresh & Clean Citrus Concept". ECOZ Lemon riecht nicht wie jedes andere synthetische Produkt mit Zitrusdüften. ECOZ Lemon ist konzentriert und enthält 100% ätherische Öle aus ausgewählten Zitrusfrüchten. Die ECOZ Lemon-Version ist sowohl unter den Sanierern, als auch bei Geschädigten, die den Duft von frischen, sauberen und natürlichen Zitrusfrüchten in ihrem Haus genießen, beliebt. Wenn es nach ECOZ Lemon riecht, dann riecht es SAUBER.
UNIVERSAL ANWENDBAR FÜR GERUCHSBESEITIGUNG UND LUFTERFRISCUNG
Ein weiterer frischer, natürlicher und energieerzeugender Zitrusduft, der die Produktpalette von ECOZ erweitert - Wir introduzieren ECOZ Summer Orange, das zusammen mit ECOZ Lemon das neue "Fresh & Clean Citrus" von NAC darstellt. Vaportek hat den Duft frisch gepresster Orangen erfolgreich eingefangen. ECOZ Summer Orange besteht aus Mandarine, Orange, Blutorange und Grapefruit usw. Summer Orange duftet frisch, schafft positive Energie, saubere Luft und gute Laune. Verwenden Sie Summer Orange in Ihrem Spülwasser beim Waschen nach Brand- und Abwasserschäden usw., beim Reinigen von Möbeln und Hausrat oder beim Auslegen von ECOZ Summer Orange mit einem Kaltvernebler und mehr. ECOZ Summer Orange ist bereits bei vielen Kunden ein Hit. Wenn es nach ECOZ Summer Orange riecht, dann riecht es SAUBER.
GEEIGNET FÜR ALLE ARTEN VON GERÜCHEN – UNSER KLASSISCHER DUFT
Eine kraftvolle Mischung aus vielen verschiedenen und speziell ausgewählten ätherischen Ölen.
ECOZ Classic Neutral ist ein Klassiker und seine Stärke und Kraft aus speziell ausgewählten ätherischen Ölen machen ihn zu einer sicheren Wahl für jede Geruchsproblematik. Classic Neutral ist wie die anderen ECOZ-Versionen ein leistungsstarkes Konzentrat, bei dem Sie etwas für Ihr Geld bekommen. ECOZ behandelt alles von Brand-/Rußgeruch, Leichengeruch, Abwassergeruch usw. und versagt nie. Das reine und leicht würzige Aroma von Classic Neutral besteht aus Eukalyptus, grüner Minze und anderen duftenden ätherischen Ölen. Classic Neutral ist eine sichere Wahl für alle Geruchsprobleme.

Reiner frischer Zitrusduft
FRESH & CLEAN CITRUS CON CEPT


Ein klassischer Allrounder Erfrischender Orangenduft
EN KLASSISK ALLROUNDER
GEEIGNET FÜR DIE NEUTRALISIERUNG VON RAUCH UND RUSS
Besonders geeignet für alle Arten von Holz-/Papier-/Eiweißbränden und nach synthetischen Bränden. Eine ausgewählte Mischung aus ätherischen Ölen für verschiedene Brand- und Rußschäden usw. Hervorragendes Produkt zur Neutralisierung von Rauch- und Rußgerüchen. ECOZ SOS ist ein geniales und wissenschaftlich formuliertes Konzentrat, bestehend aus ausgewählten ätherischen Ölen, die besonders effektiv auf Brand- und Rußgeruch reagieren. Bei vielen Kunden ein Favorit bei der Reinigung nach Brand und Rußschäden. SOS riecht mild nach Zimt, Zitrusfrüchten und anderen Duftnuancen. SOS hinterlässt einen sehr angenehmen milden Duft.
ECOZ LINEN
WERTGESCHÄTZTES UND SUPER EFFIZIENTES PRODUKT ZUR ENTFERNUNG ALLER GERUCHSARTEN IN TEXTILIEN
Wertgeschätztes und hocheffizientes Produkt zur Entfernung aller Arten von Gerüchen in Textilien. Hinterlässt einen wunderbaren und milden Duft von frisch gewaschener Kleidung/Wäsche. Fügen Sie ECOZ Linen zu Ihrer Wäsche oder Ihrem Teppich-/Möbelreiniger hinzu.
ECOZ Linen entfernt effektiv Brand- und Rauchgerüche, Schimmelgerüche, Schweißgerüche usw. Linen hinterlässt einen wunderbaren Duft von frisch gewaschener Kleidung/Wäsche.

KOSTENLOSES
Effektiv bei Brand- & Rußschäden
EFFEKTIV TIL BRAND- OG RØGSKADER



Beliebt zur Wäschereinigung

ECOZ DUFTET AM BESTEN!
Verwenden Sie Vaportek überall und jederzeit! – Verwenden Sie Ihr Vaportek Gerät vor, während und nach jeder Schadensanierung!
Welche ECOZ-Produkte soll ich wählen? Wenn Sie sich nicht sicher sind, lassen Sie sich eine Probepackung mit kleinen 250 ml Flaschen kostenlos zusenden. Oder mischen Sie einen Karton (12 x 1 Liter) zum Einführungspreis und testen Sie die Produkte selbst.




HOLEN SIE DAS BESTE AUS IHREN VAPORTEK-PRODUKTEN UND GEWINNEN SIE ZUFRIEDENE KUNDEN
VAPORTEK ECOZ GERUCHSNEUTRALISATOR-KONZENTRAT
Das Geruchsneutralisator-Konzentrat von ECOZ gehört zu unseren beliebtesten Produkten in der professionellen Schadensanierung und dafür gibt es mehrere Gründe. Effizienz und Düfte, die Ihre Kunden lieben werden!
Alle verschiedenen ECOZ-Versionen bestehen aus komplexen ätherischen Ölen, die Gerüche neutralisieren und lang anhaltendes Aroma in der Luft hinterlassen. Wenn Sie nach z.B. einem Brandschaden ein ECOZ-Produkt in Ihrem Spülwasser verwenden, bemerkt der Kunde das sofort, weil sich ein positiver Duft in der Umgebung verbreitet. Unsere Kunden beschreiben unsere ECOZ-Produkte als die mit Abstand fortschrittlichsten, best duftenden, meist konzentrierten und geruchsneutralisierenden Konzentrate in der proffessionellen Schadensanierung.



ECOZ DUFTET AM

BESTSELLER SCHADENSANIERUNG



Der Geruch von Rauch und Ruß nach dem Brand erzeugt bei den Geschädigten negative Gefühle. Die Reinigung nach Brand- oder Wasserschäden und die Verwendung eines ECOZ-Produkts verwandelt Frustration in ein Lächeln! ECOZ-Produkte riechen nicht nur gut, sie entfernen auch Gerüche effektiv.
Verwenden Sie zwei Eimer beim Waschen/Reinigen nach Bränden. Einen Eimer mit duftneutraler alkalischer Reinigungslösung und einen Eimer mit sauberem Spülwasser. Wir empfehlen 20-100 ml ECOZ-Konzentrat pro 10 Liter Spülwasser, jedoch abhängig von Geruchsart und Geruchsintensität.
Gerüche von Rauch/Ruß, die sich in der Oberfläche befinden, werden am Besten durch Hinzufügen eines geeigneten ECOZ-Produktes neutralisiert. Die ultrakleinen Moleküle der ätherischen Öle dringen in Oberflächen ein und neutralisieren den Geruch nach der Zwaardemaker Pairs Methode (siehe Seite 16 und 18). Die Oberfläche ist sauber, geruchsfrei und ohne fettende Rückstände und hinterlässt einen angenehmenen ECOZ-Duft. Nachfolgende Oberflächenbehandlung wie z.B. mit Farbe kann ohne Probleme durchgeführt werden.
Verwenden Sie ECOZ SOS oder ECOZ Classic Neutral für starken, mittleren und milden Rauch-/Rußgeruch, und ECOZ Lemon oder ECOZ Summer Orange für mildere Gerüche. Bei Bedarf können Sie anschließend einen Restorator oder VaporShark verwenden (mit Membranen/Patronen), die das gleiche Aroma wie ECOZ enthalten. Wir nennen es synergistische Geruchskontrolle. Siehe Produktdatenblatt auf Seite 31 für weitere Details.

1
Reinigungswasser mit alkalischem Reiniger


2
Spülwasser mit ECOZ-Konzentrat +

HOLEN
ECOZ-Produkte sind auch bei der Anwendung mit ULV-Kaltverneblern beliebt. Verdünnen Sie die ECOZ-Produkte immer mit Wasser und im richtigen Mischungsverhältnis. Verwenden Sie ECOZ in ULV-Kaltvernebler zur Geruchsbeseitigung in Belüftungskanälen, Kriechkeller, Anhänger und in gereinigten Räumen/Räumlichkeiten. Niemals ECOZ konzentriert anwenden!








ECOZ-Geruchsneutralisator-Konzentrate und andere Chemikalien von NAC sind mit einem Power Sprayer einfach aufzutragen. Die NAC Power Spray-Serie besteht aus einer Reihe professioneller, elektrischer Sprühgeräte, die langlebige Magnetpumpen verwenden, mit sehr guter Zuverlässigkeit und konstantem Druck bei perfekten und gleichmäßigen Sprühmuster. Die elektrischen Sprühgeräte sind für die Brand- und Wasserschadensanierung entwickelt und sorgen für schnelle und optimale Ergebnisse mit allen chemischen Produkten von NAC. Wir bei NAC Europe wissen, dass es für jeden Schadensanierer ein wichtiger Motivationsfaktor ist, mit Werkzeug zu arbeiten, das einen einfachen, schnellen und effizienten Arbeitsvorgang ermöglicht, was grosse Arbeitszufriedenheit schafft und die besten Ergebnisse erzielt. "Gutes Werkzeug ist die halbe Arbeit".













HOLEN SIE DAS BESTE AUS IHREN VAPORTEK-PRODUKTEN UND GEWINNEN SIE ZUFRIEDENE KUNDEN
ECOZ-Konzentrate sind auch zur Anwendung bei Hausratsanierung beliebt. Fügen Sie ECOZ Lemon, Summer Orange oder Classic Neutral beim Waschen/Reinigen aller Arten von Gegenständen zu Ihrem Wasch- oder Spülwasser hinzu. Zur Reinigung von abwaschbaren Gegenständen, z.B. Geschirr, Puppen, Kunstgegenstände, dekorative Inneneinrichtung, Porzellan, Keramik, Lampen, Haushaltsgeräte, usw. Hausrat, der an den Geschädigten zurückgegeben wird, darf keinen Geruch von Ruß/Rauch mehr haben. Das lösen Vaportek‘s wirksame ECOZ-Produkte. Damit fügen Sie dem Hausrat einen gut riechenden Duft hinzu, den Ihre Kunden geniessen werden. Begeisterte Kunden bedeutet Alles!



5 GERUCHSENTFERNUNG BEI TEXTILIEN NACH BRAND USW.
Fügen Sie Ihrer Waschmaschine ECOZ Linen hinzu. ECOZ Linen entfernt effektiv Rauch- und Rußgeruch und hinterlässt einen sauberen und frischen Duft. Wenn Sie einen Geruchsentferner ohne Duft/ätherische Öle wünschen, empfehlen wir unsere neuen, revolutionäre und patentierte Produkte von Odorklenz z.B. OdorKlenz Laundry Additive, das alle Gerüche und Chemikalien von allen waschbaren Textilien mit natürlichen Erdmineralien neutralisiert und entfernt. ECOZ Linen und OdorKlenz sind die besten Lösungen zur Geruchsbeseiigung von Textilien auf dem Markt. Wir empfehlen die Produkte separat zu verwenden.






6 GERUCHSENTFERNUNG BEI TEPPICHEN, GEPOLSTERTEN MÖBELN USW.
Nach Brand und anderen Geruchsschäden, fügen Sie ein wenig ECOZ Linen, Classic Neutral, Summer Orange oder Lemon dem Spülwassertank Ihrer Teppich/Möbelreinigungsmaschine hinzu und Ihre Teppiche und Möbel werden geruchsneutral und riechen wieder fantastisch.



SEITE 32-33
HOLEN SIE DAS BESTE AUS IHREN VAPORTEK-PRODUKTEN UND GEWINNEN SIE ZUFRIEDENE KUNDEN
BIO-ENZYMATISCHE REINIGUNG UND GERUCHSENTFERNUNG
Die komplexe Mischung verschiedener ätherischer Öle, sowie der Inhalt von speziell ausgewählten Mikroorganismen und Enzymen, trägt zu einem schnellen und vollständigen Abbau des Geruchs bei, der mit biologischen/organischen Schäden zusammenhängt, z.B. Geruch von Abwasser, Fäkalien, Leichen, organischem Hausmüll, Urin, Schädlingen, Erbrochenem usw. Tragen Sie Bio-C auf alle kontaminierten Oberflächen mit einer Gießkanne, einem ULV-Kaltvernebler, einem Scandi-Jet-Sprühgerät von NAC, Drucksprüher usw. auf. Oder fügen Sie Bio-C in Fettabscheider, Abflüsse und dergleichen mit Dosierpumpen hinzu. Wenden Sie sich bezüglich technischer Fragen zur Dosiertechnik an NAC.
1 Wenn die Pflanzenextrakte mit Geruch in Kontakt kommen, reagieren die Pflanzenölmoleküle mit den Geruchsmolekülen, in dem sie eingekapselt und neutralisiert werden. Der Prozess wirkt sofort und ist keine Maskierung von schlechten Gerüchen, sondern eine echte Geruchsneutralisation.
2 Bio-C enthält eine spezielle Suspension von unschädlichen Bakterienkulturen sowie Enzymen, die schlechte Gerüche und organisches Material abbauen und in organische Substanzen, in Wasser und Kohlendioxid umwandeln. Die Quelle des schlechten Geruches ist dauerhaft entfernt.
Sprühen Sie Bio-C auf die betroffenen Oberflächen. Je nach Ausmaß des Schadens möglicherweise vor der Behandlung mit Bio-C reinigen und desinfizieren. Wenden Sie sich im Zweifelsfall an NAC, um genaue Anweisungen zu erhalten.
Entfernen Sie den Schädling, wenn möglich. Versprühen Sie Bio-C und platzieren Sie Neutrox Gamma Bricks als zusätzliche Vorbeugung von Geruchsbelästigungen. Falls erforderlich, desinfizieren Sie den Bereich vor der Behandlung mit Bio-C.
Die Beseitigung von Gerüchen nach Leichenfunden kann sehr kompliziert und umfangreich sein. Bio-C ist Teil von NAC's Geruchs-Management Konzept, zur effektiven Entfernung von Gerüchen in der Schadensanierung. Weitere Informationen über unser Odor Management Concept, einschließlich Bio-C, erhalten Sie von NAC.
Verwenden
BIO-C ENTFERNT BIOLOGISCHEN/ORGANISCHEN GERUCH







HOLEN SIE DAS BESTE AUS IHREN VAPORTEK-PRODUKTEN UND GEWINNEN SIE ZUFRIEDENE KUNDEN
4 ENTFERNUNG UND ZERSETZUNG VON BIOLOGISCHEM ABFALL
Bio-C baut schlechte Gerüche ab und entfernt sie von Oberflächen, die mit organischer Substanz in Kontakt gekommen sind, wie z.B. Abfälle von Fleisch, Obst, Gemüse, Blumen, Brot, Milch und Käse usw. Bio-C wird direkt auf diese kontaminierten Oberflächen, die typischerweise in Müllbereichen usw. zu finden sind, gesprüht. Die ätherischen Öle von Bio-C sorgen sofort für eine wirksame Geruchsreduzierung und die wirksamen Mikroorganismen und Enzyme werden im folgenden den Abfall zersetzen und in Wasser und Kohlendioxid (CO2) umwandeln, genau wie in der Natur.
Die aktiven Bakterien und Enzyme von Bio-C sorgen für eine vollständige Geruchsentfernung und -abbau von Fettansammlungen in Fettabscheidern, Abflüssen und anderen Anlagen, die in Kontakt mit Abwasser aus der Lebensmittelindustrie, gewerblichen Großküchen, Restaurants usw. kommen. Dosiersysteme können eingerichtet werden. Weitere Informationen erhalten Sie von NAC Europe.
Bio-C kann direkt in Küchenhauben und Abluftkanälen in der Lebensmittelindustrie, Grossküchen, Restaurants etc. mit speziellen Düsen-/Pumpendosiersystemen injiziert werden. Bio-C entfernt/baut Fett ab und hält den exponierten Bereich frei von Ansammlungen von Bratfett, Bratöl und anderen Verunreinigungen und damit auch von weiteren Geruchsbelästigungen. Weitere Informationen über Dosiersysteme erhalten Sie von NAC Europe.
Reinigung/Geruchssanierung von besonders schmutzigen und vernachlässigten Wohnungen kann mit verschiedenen Vaportek-Produkten durchgeführt werden. Bio-C kann direkt sowohl auf alle porösen, als auch auf alle harten Oberflächen gesprüht werden. Das gilt für z.B. verputzte Wände, Tapeten, Beton, Holz, Teppiche, Vorhänge, Fliesen usw. Zuerst gründlich reinigen. In diesem Prozess können Sie Vaportek ECOZ-Konzentrate im Spülwasser verwenden oder direkt mit parfümneutralen Reinigungsmitteln.
Bio-C entfernt den Uringeruch von Katzen, Hunden und anderen Haustieren. Entfernt effektiv Uringeruch von Inkontinens in Bettwäsche, Teppichen und allen anderen Materialien und Oberflächen. Entfernt den Uringeruch in und um Urinale und ist besonders wirksam beim Abbau des Uringeruches von porösen Fugen um Urinale, Toiletten usw. Wenden Sie sich an NAC Europe, um spezifische Informationen zu erhalten, da möglicherweise Bio-C mit anderen Produkten zur Geruchsbekämpfung, die Teil des neuen Geruchs Management Konzepts von NAC sind, kombiniert werden können.





ERZIELE DAS BESTE AUS DEN VAPORTEK-PRODUKTEN UND GEWINNE ZUFRIEDENE KUNDEN
Der Restorator ist ein einzigartiges, kompaktes und sehr vielseitiges Geruchsbeseitigungsgerät, das Ihnen hilft Gerüche sofort zu entfernen und Ihre Kunden werden begeistert sein. Der Restorator ist ein unverzichtbares Werkzeug für Tausende von Sanierungsunternehmen weltweit.
Der Restorator kann sofort nach dem Brand angwandt werden. Die Geschädigten, Nachbarn usw. sind frustriert über den starken Geruch von Ruß. Hier kann der Restorator, zusammen mit anderen Vaportek-Produkten wie Neutrox Gamma Bricks, SOS Bricks und ECOZ-Konzentraten helfen den starken und störenden Geruch von Rauch und Ruß zu reduzieren mit dem Ergebnis, daß Beschwerden über Geruchsbelästigungen reduziert oder vermieden werden.




Der Restorator eignet sich besonders zur dauerhaften Beseitigung von Geruchsbelästigungen nach einem Brand usw. und kann während des gesamten Sanierungsprozesses verwendet werden. Das Standardverfahren besteht darin, alle Oberflächen mit einem alkalischen Reinigungsmittel zu waschen und ECOZ-Konzentrate in Ihr Spülwasser hinzu zufügen. Danach können Sie den Restorator verwenden, der jeden Restgeruch entfernt. Wir empfehlen die Verwendung einer Patrone mit SOS Öl (Smoke Odour Solution) oder mit Original Neutrox Gamma Öl im Restorator. Zur milden Geruchsentfernung sind unsere frischen Lemon und Summer Orange Patronen aus unserem Fresh & Clean Citrus Concept sehr beliebt.

Wasser mit alkalischem Reiniger


Spülwasser mit ECOZ-Konzentrat SOS, Classic Neutral, Lemon oder Summer Orange




Vaportek ist Erste Hilfe gegen Geruch. Keine Beschwerden und zufriedene Kunden.




ERZIELE DAS BESTE AUS DEN VAPORTEK-PRODUKTEN UND GEWINNE ZUFRIEDENE KUNDEN
3 GERUCHSSANIERUNG – AUTOS, WOHNWAGEN, BOOTE USW.
Beliebtes Gerät zum Entfernen von Gerüchen in Autos, Wohnwagen, Booten und dergleichen. Bei Bedarf zuerst mit Bio-C- oder ECOZ-Konzentraten auf Textilien und harte Oberflächen auftragen/waschen.


4 BESSERE VERBREITUNG DES TROCKENDAMPFES IN GROSSEN RÄUMEN
Stellen Sie den Restorator vor den Lufteinlaß eines Radial- oder Axial ventilators und der aktive Trockendampf wird effektiv auf eine größere Fläche verteilt.

GERUCHSSANIERUNG – HAUSRAT UND MÖBEL
Der Restorator kann zur Geruchsbehandlung von Hausrat und Textilien verwendet werden. Die Pflanzenöl-Moleküle aus dem aktiven Trockendampf dringen schnell in Materialien und Textilien ein. Wir empfehlen die Verwendung von Vaportek Lemon oder SOS Patronen für diesen Zweck.
Der Restorator ist ideal für die Geruchsbeseitigung in Hotelzimmern, wenn das Rauchverbot nicht eingehalten wurde oder zur Beseitigung von anderen unangenehmen Gerüchen wie Schweiß, Erbrochenem, Urin, Essen usw. Hotelzimmer, die schlecht riechen, können nicht genutzt werden und das kostet jede Nacht viel Geld, wenn das Zimmer nicht vermietet wird. Sprühen Sie je nach Bedarf zuerst mit Bio-C direkt auf die Stellen, wo die Geruchsquelle lokalisiert werden kann. Entfernen Sie die Geruchsquelle, z.B. Erbrochenes. Reinigen Sie den Bereich und sprühen Sie ihn dann mit Bio-C ein. Danach wird der Restorator verwendet, der effektiv den Geruch im ganzen Raum via aktivem Trockendampf entfernt/beseitigt. Hausdamen und Dienstmädchen in Hotels weltweit sind begeistert über die Fähigkeit des Restorators und von Bio-C die Gerüche schnell, effektiv und umweltfreundlich beseitigen zu können.







ERZIELE DAS BESTE AUS DEN VAPORTEK-PRODUKTEN UND GEWINNE ZUFRIEDENE KUNDEN
VAPORSHARK
Extrem leistungsstarkes und effektives Gerät zur dauerhaften Entfernung von schlechten Gerüchen. Sie behandeln die Räume, Gebäude und RLTAnlagen usw. mit einem sauberen, frischen und natürlichen Geruch. Eine ausgezeichnete und umweltfreundliche Alternative zur Ozonbehandlung.
SEITE 20-21 L ESEN S IE MEH R

Erste Hilfe gegen Rauch- und Rußgeruch nach Brandschäden in großen Gebäuden wie z.B. Kaufhäuser, Schulen, Einkaufszentren, Fabrikhallen, Lagerhäuser, Büros usw.

Nach einem Brand in großen Bereichen kann der Rauch- und Rußgeruch eine große Belastung für Mitarbeiter und Besucher in den geruchsbelasteten Gebäuden sein. Hier bietet sich VaporShark als eines der wenigen Produkte auf dem Markt an, wo Erste Hilfe geleistet werden kann, um Gerüche sofort zu reduzieren, das Raumklima zu verbessern und so Geruchsbeschwerden von Mitarbeitern, Gästen, Besuchern usw. zu vermeiden.
A: In großen Bereichen können Sie einen oder mehrere VaporSharks platzieren, die den Geruch sofort reduzieren. Der VaporShark verbreitet schnell den bekannten, wirksamen und geruchsneutralisierenden Trockendampf von Neutrox Gamma Öl, SOS Öl (Smoke Odour Solution) oder die natürlichen Zitrus Öle aus unserem "Fresh & Clean Citrus Concept", Lemon oder Summer Orange.
B: Bei sehr großen Räumen/Hallen können Sie die Wirkung des VaporSharks erhöhen, indem Sie den Luftauslaß des VaporSharks vor dem Lufteinlaß z.B. eines Radialgebläses platzieren (siehe Bild 2), das dann den Trockendampf über größere Flächen verteilt. Sie können mehrere VaporSharks in großen Räumen verwenden und stellen damit sicher, daß der gesamte betroffene Bereich mit Vaporteks geruchsneutralisierendem Trockendampf behandelt wird, zur Zufriedenheit der Mitarbeiter und Besucher.
C: Alternativ können Sie auch einen VaporShark an das zentrale Lüftungssystem anschließen (siehe Bild 2), um alle Räume im Gebäude mit aktivem Trockendampf vom VaporShark zu behandeln. Durch Einführen eines 2-Zoll-Flexschlauchs vom Luftauslaß des VaporSharks direkt in den Lüftungskanal, breitet sich der aktive Trockendampf über das Lüftungssystem in alle betroffenen Räume aus und beseitigt so Geruchsbelästigungen.
1

2





ERZIELE DAS BESTE AUS DEN VAPORTEK-PRODUKTEN UND GEWINNE ZUFRIEDENE KUNDEN
Der VaporShark kann sofort nach dem Brand verwendet werden. Die Geschädigten, Nachbarn usw. sind frustriert über den starken Geruch von Ruß. Hier kann der VaporShark zusammen mit anderen Vaportek-Produkten wie Neutrox Gamma Bricks, SOS Bricks und ECOZ-Konzentraten helfen den starken und störenden Geruch von Rauch und Ruß zu reduzieren mit dem Ergebnis, daß Beschwerden über Geruchsbelästigungen reduziert oder vermieden werden.






Vaporshark eignet sich besonders zur dauerhaften Beseitigung von Geruchsbelästigungen nach einem Brand usw. und kann während des gesamten Sanierungsprozesses verwendet werden. Das Standardverfahren besteht darin, alle Oberflächen mit einem alkalischen Reinigungsmittel zu waschen und ECOZ-Konzentrate in Ihr Spülwasser hinzu zufügen. Dazu können Sie den VaporShark verwenden, der jeden Restgeruch entfernt. Wir empfehlen die Verwendung einer Membran mit SOS Öl (Smoke Odour Solution) oder mit Neutrox Gamma Öl im VaporShark. Zur leichten Geruchsentfernung sind unsere frischen Lemon und Summer Orange Membranen aus unserem "Fresh & Clean Citrus Concept" sehr beliebt.

Wasser mit alkalischem Reiniger

Spülwasser mit ECOZ-Konzentrat
SOS, Classic Neutral, Lemon oder Summer Orange




Vaportek ist Erste Hilfe gegen Geruch. Keine Beschwerden und zufriedene Kunden.

ERZIELE DAS BESTE AUS DEN
ZUFRIEDENE KUNDEN
VAPORTEK-PRODUKTEN UND GEWINNE
Stellen Sie den VaporShark vor den Lufteinlaß eines Radial- oderAxiallüfter oder eines anderen Gebläses und der aktive Trockendampf wird effektiv auf eine größere Fläche verteilt.






Vaporshark kann zur Geruchsbehandlung von Hausrat und Textilien verwendet werden. Die Pflanzenöl-Moleküle aus dem aktiven Trockendampf dringen schnell in Materialien und Textilien ein. Wir empfehlen die Verwendung von Vaportek Lemon oder SOS Membranen für diesen Zweck.

6 GERUCHSENTFERNUNG IN HOHLRÄUMEN UND ANDEREN SCHWER ERREICHBAREN RÄUMEN
Es kann schwierig sein, Gerüche in schwer zugänglichen Bereichen zu behandeln, aber auch hier kann der VaporShark helfen. Durch Anbringen eines 2-Zoll-Flexschlauchs am Luftauslaß des VaporSharks, können Sie aktiven geruchsneutralisierenden Trockendampf gezielt in schwer zugängliche Bereiche wie Bodentrennungen, Kriechräume, Dachböden, unter Fußböden und alle anderen Arten von Hohlräumen, wo Trockendampf über Flexschläuche injiziert werden kann, transportieren.












Führende Automobilhersteller weltweit nutzen und empfehlen die Vaportek-Technologie für ihr weltweites Händlernetzwerk. Warum? Weil Vaportek eine umweltfreundliche Technologie anwendet, immer wirkt und einfach zu bedienen ist. Autos, die schlecht riechen, können nicht verkauft werden – Vaportek löst dieses Problem auf umweltfreundliche und effiziente Weise.
Neben Autohändlern verwenden auch andere Branchen und Geschäftsbereiche z.B. Vaporteks Restorator, wie hier abgebildet. Weltweit haben Hotels, Restaurants, Immobilienmakler, Transportunternehmen, Reinigungsunternehmen, Schadensdienstleister, Schädlingsbekämpfungsunternehmen, die Industrie und viele andere sehr von den vielseitigen, umweltfreundlichen und hochwirksamen Produkten von Vaportek profitiert.


Sind Sie OEMs (Original Equipment Manufacturer) also der ursprüngliche Produkthersteller und interessiert mehr darüber zu erfahren, wie die Technologie von Vaportek in Ihre Produkte/Produktlösungen integriert werden kann, dann kontaktieren Sie uns bitte. Vaportek arbeitet zusammen mit Herstellern von Ausrüstung und Anlagen für Luftreinigung, Luftveredelung, Aromatherapie, Produkte für die Abfallwirtschaft, Abwasser usw. Vaportek stellt gerne spezielle Lösungen für Ihre Bedürfnisse und Zwecke her. Die vielseitige Produktpalette von Vaportek kann eine Lösung für Ihre spezifischen Bedürfnisse finden.
Implementieren Sie eine einzigartige und nachhaltige Lösung in Ihre Maschinen, Prozesse und Ausrüstung usw. um Gerüche zu entfernen oder zu kontrollieren. Nutzen Sie die Kraft der Natur, die grosse Erfahrung von Vaportek und ein vielseitiges und effizientes Produktportfolio. Zusammen finden wir die perfekte Lösung.
Wir sind daran interessiert, mehr über Ihre Gedanken und Ideen zu erfahren. Wir bieten Ihnen eine kreative und nachhaltige Lösung. Kontaktieren Sie uns für ein unverbindliches Gespräch!




"DAS BESTE AUS ZWEI WELTEN"
NAC Europe wurde 2001 gegründet, mit Vaportek als eines unserer wichtigsten Produkte in unserer damals bescheidenen Produktpalette.
Seit 2001 hat NAC Europe seine Produktpalette mit technischer Ausrüstung und Chemie usw. aus einer Reihe von anerkannten und innovativen internationalen Herstellern erweitert. Im Jahr 2024 präsentierten wir auf unserer neuen Website eine Reihe neuer Produkte sowie mehrere neue Konzepte, darunter ein völlig neues Geruchssanierungskonzept, das auf "Das Beste aus zwei Welten" basiert.
Vaportek ist und bleibt einer unserer Bestseller, einfach weil die Technologie und Produkte von Vaportek so einzigartig, effektiv und vielseitig in ihrer Anwendung sind.
NAC Europe ist in der Branche als das Unternehmen bekannt, das seinen Kunden durch die Einführung neuer Technologien, neue und mehr Vorteile in einer Branche, die schnelle und effektive Ergebnisse braucht, verschafft.
Vaportek basiert auf natürlichen Pflanzenextrakten und arbeitet in einfachen, speziellen Prozessen, bei denen die natürlichen und kraftvollen ätherischen Öle mit Geruchsmolekülen in einem Prozess namens "Zwaardemaker Pairs" reagieren. Siehe Seite 16-18.
Jetzt stellt NAC ein neues Konzept vor, mit dem wir Vaportek mit neuen Produkttechnologien, die durch Oxidation und Adsorption arbeiten, verbinden. Mit dem neuen Konzept wollen wir unseren Kunden die Möglichkeit geben die verschiedenen Methoden zur Geruchsbeseitigung zu kombinieren, um Geschwindigkeit und Effizienz, Nachhaltigkeit und Benutzerfreundlichkeit bei der Geruchsbeseitigung zu optimieren.
Wir hoffen, daß unsere Kunden unser neues Konzept willkommen heißen werden.

Brand- und Wasserschadensanierung
Wir haben die besten und die neueste Technologien zur professionellen Geruchsbeseitigung in einem Konzept, das wir "DAS BESTE AUS ZWEI WELTEN" nennen, vereint.
Das Konzept steht für Vielseitigkeit, Kraft, schnelle Ergebnisse, Umwelt- und Benutzerfreundlichkeit und zufriedene Kunden.
















BRAND- UND WASSERSCHADEN
Schadensanierungsunternehmen weltweit haben seit den frühen 80'er Jahren von der Vaportek-Technologie profitiert und gehören heute zu den Vaportek Kernkunden. Vaportek-Produkte sind unter Fachleuten hoch angesehen, weil Vaportek dem Sanierungsunternehmen viele Möglichkeiten bietet den Geruch umweltfreundlich zu kontrolieren und zu zu entfernen.
Die umweltfreundlichen Vaportek-Produkte tragen zu einer effektiven und dauerhaften Geruchsentfernung während des gesamten Sanierungsprozesses bei
und zeichnen sich durch ihre Vielseitigkeit aus. Vaportek eignet sich bei Brandschäden, Wasserschäden, Abwasserschäden, Geruchsschäden durch Schädlinge, bei der Sanierung von Gerüchen nach Leichenfunden usw. Vaportek kann alleine oder zusammen mit anderen Geruchsbeseitigungsmethoden, beispielsweise NAC´s Produkte auf der Basis von CLO2 (Chlordioxid) oder H2O2 (Wasserstoffperoxid) verwendet werden. Kontaktieren Sie uns für weitere Informationen. Vaportek ist das Hauptprodukt von NAC's neuem innovativen GeruchssanierungsKonzept "NAC EUROPE´S ODOUR MANAGEMENT Konzept".
TIERPRAXIS, ZWINGER, HAUSTIERE
Geruch von Haustieren in Privathäusern, Tierpraxis, Zwinger usw. ist ein bekanntes
Problem. Hier kann man Vaportek-Produkte verwenden, um den Uringeruch und andere Gerüche auf sowohl harten, wie auch porösen Oberflächen wie Texti-
lien usw. zu neutralisieren.
Bio-C, Neutrox Gamma Bricks und Restorator sind Beispiele für Vaportek-Produkte, die helfen die störende Gerüche der Haustiere zu reduzieren oder zu entfernen.
REINIGUNG
Die Reinigungsbranche kann die Vaportek-Technologie effektiv nutzen. In den vergangenen Jahren ist der Trend in der Reinigungsbranche mit Produkten zu reinigen, die ein Umweltzeichen haben und ohne Duftstoffe sind. Künstliche Duftstoffe maskieren den Geruch und sind deshalb keine umweltfreundliche Lösung für Geruchsprobleme in Institutionen wie Schulen, Pflegeheime, Industrieunternehmen usw. Doch ist es notwendig Gerüche zu entfernen und zu kontrollieren.
Vaportek kann in allen Innenräumen verwendet werden. Vaportek-Produkte beinhalten 100% natürliche ätherische Öle. Der Geruch kann von mehreren Quellen wie Urin, Hausmüll, Tabakgeruch, Erbrochenem, Abwasser, Schimmel, Schweiß usw. stammen. Mit dem breiten Vaportek-Sortiment finden wir immer eine gemeinsamme Lösung mit unseren Kunden effektiv und umweltfreundlich schlechte Gerüche zu kontrollieren und zu beseitigen. Reinigung

Hausverwaltung
Makler


Gewächshäuser
HAUSVERWALTUNG UND MAKLER
Geruch in vergammelten Wohnungen und Häusern, wo viele Jahre geraucht wurde, Haustiere, Urin, Leichengeruch, Schimmel usw. können große Herausforderungen sein um den Geruch zu entfernen, wenn neue Mieter die Wohnung übernehmen.
Mit 20 Jahren Erfahrung in der Schadenssanierung, hat NAC Europe die Kompetenzen und Produkte für eine 100% effektive Geruchsentfernung schlechtriechenden Häusern/Wohnungen. Das bedeutet keine Beschwerden bei Übernahme sowie schneller Verkauf von Immobilien.
GESUNDHEITS- UND PFLEGESEKTOR
Krankenhäuser, Pflegeheime, Wohngemeinschaften usw. sind oft von Geruch von Urin (Inkontinenz), Fäkalien, Erbrochenem, Schweiß, Tabakgeruch usw. geplagt. In den späten 70'er Jahren wurde Vaporteks Technologie entwickelt, ursprünglich um schlechte Gerüche in
Krebsstationen amerikanischer Krankenhäuser zu entfernen und das brachte Vaportek weltweiten Erfolg. Heute werden Vaporteks Produkte von Tausenden von Institutionen weltweit verwendet. Geruch wird wirksam und umweltfreundlich bekämpft.
GEWÄCHSHÄUSER/ CANNABIS PRODUKTION
Die Verwendung verschiedener Arten von Düngemitteln und anderen Nährlösungen, hohe Luftfeuchtigkeit und Bakterienwachstum usw. kann zu Geruchsbelästigungen in Gewächshäusern führen. Mit der zunehmenden Produktion von Cannabis für medizinische Zwecke sind auch Geruchsprobleme im Zusammenhang hiermit entstanden. Cannabispflanzen produzieren Terpene, was für den charakteristischen Geruch der Pflanze verantwortlich ist. Terpene riechen stark nach Kohlenwasserstoffen, welches zum
Schutz vor Pflanzenfressern oder für das Anziehen von Raubtieren, dient. Der Geruch bei der Cannabisproduktion kann ein Geruchsproblem für die Nachbarn werden. Vaportek's aktiver Trockendampf bestehend aus vielen verschiedenen Pflanzenextrakten (ätherischen Ölen), hat sich über Jahre als sehr wirksam bei der Geruchsbeseitigung der stark riechenden Terpenen erwiesen. NAC Europe bietet Vaportek Geruchsbehandlungsprodukte sowie fortschrittliche Mittel zur Desinfektion des Bewässerungswasser in der proffessionellen Pflanzenproduktion an.







Keine Hotelgäste akzeptieren schlechten Geruch in Hotelzimmern. Geruch von Tabak, Erbrochenem, Schweiß usw. in Hotelzimmern machen den Raum unmöglich zum vermieten und kosten jedes Jahr Hotels viel Geld durch verlorene Einnahmen und Ansehen. Führende Hotelketten weltweit vertrauen auf Bio-C flüssiges Konzentrat, Neutrox Gamma und Aroma
Bricks oder den Restorator usw. für eine super effiziente und vollständige Geruchsentfernung innerhalb von 30-60 Min. oder kürzer, mit Garantie. Ob es um den Geruch von Abfall, Rauch, Erbrochenem, Urin in Hotelzimmer, Hotelkorridore, Toiletten usw. geht, gibt es immer einen oder mehrere Vaportek-Produkte, die die Aufgabe sofort lösen.
Lebensmittelindustrie, Kläranlagen, Abfallverbrennung, Biogasanlagen, Tierverwertungsanlagen usw. haben gemeinsam, daß jeder einen oder mehrere Produktionsprozesse hat, der schlechten Geruch verursacht.
In Produktionshallen können Gerüche von Abwasser, Fettabscheidern, Geruch aus Rohstofflagerung, Geruch in Abfallräumen usw. auftreten, die sich auf benachbarte
Räume und Einrichtungen ausbreiten und zu großen Unannehmlichkeiten für die Mitarbeiter, Besucher, Anwohner usw. führen.
Vaportek-Produkte, wie Bio-C, VaporShark, Neutrox Gamma Bricks, HeavyDutyStand-alone Patronen usw. können für eine wirksame Behandlung und Geruchsneutralisation in vielen verschiedenen Bereichen der Industrie verwendet werden.
Die Transportindustrie kann viele Herausforderungen mit Gerüchen in Personenwagen, Lastkraftwagen, Containern usw. haben. Da starke Gerüche typischerweise den Geruch an die neuen Produkte abgeben und in Verpackungen eindringen, kann ein LKW oder Container mit Geruchsproblemen z.B. aufgrund Transport mit übelriechenden Produkten, nicht mehr
verwendet werden, bis der Geruch verschwunden ist.
Auch Tabak-, Schweiß- und Hundegeruch können in Personwagen Probleme geben. Vaportek hat viele verschiedene Lösungen für die Transportindustrie, die Gerüche im Innenraum beseitigen können.
Vaportek FAKT
Der Geruchssinn ist direkt verbunden mit dem Bereich des Gehirns, das limbische System, der das Gedächtnis, Emotionen und instinktives Verhalten steuert.
Riecht es sauber und gut, nach fertiger Arbeit - wird es vom Kunden als positiv wahrgenommen.
Positives Branding Ihres Unternehmens stärkt damit Ihre Wettbewerbsfähigkeit deutlich.


Vaportek-Produkte sind WIRTSCHAFTLICH & UMWELTFREUNDLICH
Vaportek-Produkte sind REINE PFLANZENENERGIE BASIEREND AUF DEN KRÄFTEN DER NATUR
Vaportek-Produkte sind EINFACH ANZUWENDEN
Die Vaportek-Methode ist keine Maskierung des Geruches, sondern eine vollständige Geruchsneutralisation basierend auf der Verwendung von "VAN DER WAAL‘S FORCE" und "ZWAARDEMAKER PAIRS". Siehe Seite 16-18.

Vaportek-Produkte bieten viele MÖGLICHKEITEN

ERSTE HILFE GEGEN GERUCH
ÜBERNEHMEN SIE 100% KONTROLLE ÜBER IHRE GERUCHSBESEITIGUNG




